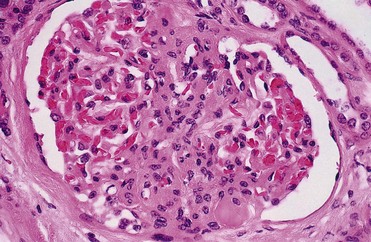
image

chapter 40 Pathophysiology of Urinary Tract Obstruction
Obstruction of the urinary tract can occur during fetal development, childhood, or adulthood. The point of obstruction can be as proximal as the calyces and as distal as the urethral meatus. The cause of obstruction may be congenital or acquired and benign or malignant. The impact of the obstruction is influenced by the extent or degree of obstruction (partial or compete, unilateral or bilateral), its chronicity (acute or chronic), the baseline condition of the kidneys, the potential for recovery, and the presence of other mitigating factors such as urinary infection. These may ultimately lead to permanent renal damage, which may result in limiting the excretion of metabolic wastes and altering water and electrolyte balance.
Certain terms used in this chapter as descriptors of this process need to be defined from the outset. Hydronephrosis is the dilation of the renal pelvis or calyces. It may be associated with obstruction but may be present in the absence of obstruction. Obstructive uropathy refers to the functional or anatomic obstruction of urinary flow at any level of the urinary tract. Obstructive nephropathy is present when the obstruction causes functional or anatomic renal damage.
Prevalence of the Problem
The prevalence of urinary tract obstruction is best estimated from autopsy series. In a series of 59,064 autopsies performed on individuals ranging from neonates to geriatric subjects, hydronephrosis was reported in 3.1% (Bell, 1950). There were no gender differences in this series until the age of 20 years. However, hydronephrosis was more prevalent in women in the 20- to 60-year interval. The latter was attributed to pregnancy and development of gynecologic malignancies. It was more prevalent in males after age 60 years, because of prostatic diseases. Hydronephrosis has been reported to be present in 2% to 2.5% of children subjected to autopsy (Campbell, 1970; Tan et al, 1994). It is somewhat more prevalent in boys, and the majority of cases were in subjects younger than 1 year. The aforementioned prevalences are most likely an underestimate of obstructive events, because temporary bouts of obstruction such as those induced by prior pregnancy or stone episodes were not captured.
There are no new data regarding the prevalence and incidence of obstructive uropathy. However, there are new data on ureteropelvic junction obstruction and ureterocele that may permit certain inferences. Based on the United States published and coded data on ureteropelvic junction obstruction generated by the Healthcare Cost and Utilization Project (HCUP) and Kids’ Inpatient Database (KID), the number of inpatient hospitalizations for ureteropelvic junction have decreased from 1.1 per 100,000 in 1994 to 0.8 per 100,000 in 2000. Although this may be influenced by a shift to more outpatient procedures or observational management, it could also be due to a decreasing incidence of this problem (Schulam et al, 2007). However, this has not been demonstrated for those afflicted with ureterocele where the rates have been stable over this interval (Pohl et al, 2007).
The pathophysiology of obstructive nephropathy is discussed in detail in the beginning of this chapter to provide a platform for understanding the clinical ramifications of this process, some of which are detailed in later sections that focus on unique causes of this problem. The mechanisms of obstructive nephropathy are unveiled at genetic, molecular, cellular, glomerular, renal tubular, whole kidney, and systemic levels. The impact of obstruction on the fetal and developing kidney is not emphasized because this is covered in other sections of this book. A list of possible causes of obstructive nephropathy is provided in Table 40–1.
Table 40–1 Possible Causes of Obstructive Nephropathy
| Renal | |
| Congenital | Polycystic kidney |
| Renal cyst | |
| Peripelvic cyst | |
| Ureteropelvic junction obstruction | |
| Neoplastic | Wilms tumor |
| Renal cell carcinoma | |
| Transitional cell carcinoma of the collecting system | |
| Multiple myeloma | |
| Inflammatory | Tuberculosis |
| Echinococcus infection | |
| Metabolic | Calculi |
| Miscellaneous | Sloughed papillae |
| Trauma | |
| Renal artery aneurysm | |
| Ureter | |
| Congenital | Stricture |
| Ureterocele | |
| Obstructing megaureter | |
| Retrocaval ureter | |
| Prune-belly syndrome | |
| Neoplastic | Primary carcinoma of ureter |
| Metastatic carcinoma | |
| Inflammatory | Tuberculosis |
| Amyloidosis | |
| Schistosomiasis | |
| Abscess | |
| Ureteritis cystica | |
| Endometriosis | |
| Miscellaneous | Retroperitoneal fibrosis |
| Pelvic lipomatosis | |
| Aortic aneurysm | |
| Radiation therapy | |
| Lymphocele | |
| Trauma | |
| Urinoma | |
| Pregnancy | |
| Radiofrequency ablation | |
| Bladder and Urethra | |
| Congenital | Posterior urethral valve |
| Phimosis | |
| Hydrocolpos | |
| Neoplastic | Bladder carcinoma |
| Prostate carcinoma | |
| Carcinoma of urethra | |
| Carcinoma of penis | |
| Inflammatory | Prostatitis |
| Paraurethral abscess | |
| Miscellaneous | Benign prostatic hypertrophy |
| Neurogenic bladder | |
| Urethral stricture | |
Global Renal Functional Changes
Glomerular Filtration, Renal Blood Flow, Collecting System Pressure
There are many functional changes in the kidney associated with obstructive nephropathy that affect renal hemodynamic variables and glomerular filtration. These are influenced by the extent and severity of obstruction, whether the obstruction is unilateral or bilateral, and whether the obstruction currently persists or has been relieved. A brief discussion of the determinants of glomerular filtration is in order to understand the interrelationships between changes in renal hemodynamics and alterations in the glomerular filtration rate (GFR) during and after obstruction. Factors influencing GFR are expressed in the following equation:
Kf is a glomerular ultrafiltration coefficient related to the surface area and permeability of the capillary membrane. PGC is the glomerular capillary pressure, which is influenced by renal plasma flow and the resistances of the afferent and efferent arterioles. The hydraulic pressure driving fluid into Bowman space is resisted by the hydraulic pressure of fluid in the tubule (PT), and also the increasing oncotic pressure (π) of the proteins remaining at higher concentrations in the late glomerular capillary and efferent arteriolar blood. Although filtered fluid is not completely free of small proteins, for practical purposes, its oncotic pressure is negligible. The net pressure determining glomerular filtration is referred to as the ultrafiltration pressure (PUF) and is derived from (PGC − PT − πGC). PGC is also influenced by renal plasma flow (RPF). RPF depends upon the renal perfusion pressure and intrarenal resistance to flow, the latter primarily mediated by the resistances in the afferent and efferent arterioles. The aforementioned relationships are depicted in the following equation:
Thus constriction of the afferent or efferent arteriole or both would reduce RPF. Constriction of the afferent arteriole results in a decrease of PGC and GFR, whereas an increase in efferent arteriolar resistance increases PGC. Whole kidney GFR depends upon factors regulating perfusion of each glomerulus and also upon the percentage of glomeruli actually filtering. For each glomerulus, the single-nephron glomerular filtration rate (SNGFR) is determined by the previously mentioned GFR equation. Obstruction can transiently or permanently alter GFR and some or all of the determinants of GFR.
The results of animal experiments are used here to profile the hemodynamic, renal, and systemic responses of renal obstruction. The limitations of animal models including the potential for a species-specific response must be taken into consideration when making analogies or comparisons with humans.
Hemodynamic Changes with Unilateral Ureteral Occlusion
There are differences between unilateral ureteral obstruction (UUO) and bilateral obstruction (BUO) that have been characterized in animal models. These include hemodynamic patterns and other factors that influence GFR. Renal blood flow (RBF) was assessed in the classical studies characterizing hemodynamic differences. In some, RBF was measured directly with various types of flow probes, and in others it was determined indirectly by measuring RPF using secretory markers and indexing this to the hematocrit. A number of vasoactive substances are thought to play a role in the changes in RBF and GFR occurring with both models of obstruction. The timing of changes in intrarenal concentrations of vasoconstrictors and vasodilators during the course of obstruction and the release of obstruction is poorly understood. The varying hemodynamic patterns during the time course of obstruction may be due to a combination of vasoactive hormones synthesized and released at different rates, physical damage to glomerular and tubular units, and extrarenal compensatory mechanisms.
Animal experiments have demonstrated a triphasic pattern of RBF and ureteral pressure changes in UUO that differs from BUO or unilateral obstruction of a solitary kidney (Fig. 40–1). With UUO, RBF increases during the first 1 to 2 hours and is accompanied by a high PT and collecting system pressure because of the obstruction. In a second phase lasting 3 to 4 hours, these pressure parameters remain elevated but RBF begins to decline. A third phase beginning about 5 hours after obstruction is characterized by a further decline in RBF, now paralleled by a decrease in PT and collecting system pressure. These changes are explained by physical alterations in flow dynamics within the kidney and are modified by changes in the biochemical and hormonal milieu regulating renal resistance.

Figure 40–1 Triphasic relationship between ipsilateral renal blood flow and left ureteral pressure during 18 hours of left-sided occlusion. The three phases are designated by roman numerals and separated by vertical dashed lines. In phase I, renal blood flow and ureteral pressure rise together. In phase II, the left renal blood flow begins to decline and ureteral pressure remains elevated and, in fact, continues to rise. In phase III, the left renal blood flow and ureteral pressure decline together.
(From Moody TE, Vaughn ED Jr, Gillenwater JY. Relationship between renal blood flow and ureteral pressure during 18 hours of total unilateral ureteral occlusion. Implications for changing sites of increased renal resistance. Invest Urol 1975;13:246–51.)
In the first phase of UUO, the increase in PT would logically be expected to reduce GFR greatly. However, this is counterbalanced by an increase in RBF related to afferent arteriolar vasodilation (Vaughan et al, 1970), which limits the fall in GFR because PGC rises. This hyperemic response has been attributed to stimulation of the tubuloglomerular feedback mechanism that relaxes the afferent arterioles as a consequence of decreased sodium delivery to the macula densa (Wright and Briggs, 1979), changes in interstitial pressure within the kidney (Vaughan et al, 1971; Francisco et al, 1980), or the release of vasodilators such as prostanoids like prostaglandin E2 (PGE2) (Allen et al, 1978). There are various lines of evidence supporting the role of prostaglandin involvement. Frøkiær and Sørensen (1995) demonstrated an increase in PGE2 excretion in the urine from the contralateral kidney after UUO. In addition, studies have shown that the increase in PGE2 and the vasodilation of the obstructed kidney could be blocked by indomethacin, a prostaglandin synthesis inhibitor (Allen et al, 1978; Blackshear and Wathen, 1978; Gaudio et al, 1980). Nitric oxide (NO) may also contribute to the early renal vasodilation in UUO. The kidney contains nitric oxide synthases (NOS) that are both constitutive (endothelial and neuronal isoforms) and inducible (iNOS). In obstructed kidneys from rabbits and rodents, iNOS increases (Salvemini et al, 1994; Miyajima et al, 2001). Furthermore, Lanzone and colleagues (1995) showed that administration of the NOS inhibitor NG-monomethyl-L-arginine (L-NMMA) before UUO attenuated the early rise in RBF, and that the renal vasodilation returned when L-NMMA was discontinued. Thus it is likely that both PGE2 and NO contribute to the net renal vasodilation that occurs early following UUO.
After this initial phase of several hours, GFR and RBF progressively decline in UUO (Jaenike, 1972; Harris and Yarger, 1974; Dal Canton et al, 1980). In contrast to the early rise in PT in the initial phases of UUO, this parameter and RBF both decline 12 to 24 hours after obstruction. This is best explained by an increase in afferent arteriolar resistance (Raff) that occurs. At this time, there are also shifts in regional blood flow in the kidney, with large portions of the cortical vascular bed not perfused or underperfused (Harris and Yarger, 1974; Gaudio et al, 1980). A shift in RBF from the outer cortex to more juxtamedullary regions was reported by Yarger and Griffith (1974) in dogs with UUO. Thus reduced whole kidney GFR at this stage of obstruction is due not only to reduced perfusion of individual glomeruli, related to afferent vasoconstriction and reduced PGC, but also to global reduction in filtration related to no perfusion or underperfusion of many glomeruli (Arendshorst et al, 1974).
Vasoconstrictors appear to play a role in the reduction in RBF after UUO. There is evidence that the renin-angiotensin system is activated during UUO, that is, during the first phase of UUO renal vein renin levels increase (Moody et al, 1975; Yarger et al, 1980) even though there is a net renal vasodilation at this time. Infusion of the angiotensin-converting enzyme (ACE) inhibitor captopril attenuates the declines in RBF and GFR in UUO, suggesting that angiotensin II is an important mediator of the preglomerular vasoconstriction occurring during the second and third phases of UUO (Ichikawa et al, 1985).
Other vasoconstrictors also appear to be involved in the reduction of RBF with UUO. Thromboxane A2 (TXA2) is also thought to be an influential postobstructive vasoconstrictor that contributes to the continued reduction in GFR and RBF. Administration of TXA2 synthesis inhibitors to the obstructed kidney limits the reduction in RBF and GFR (Klotman et al, 1986; Loo et al, 1987; Purkerson and Klahr, 1989). TXA2 may be generated in the kidney itself, perhaps in glomeruli (Yanagisawa et al, 1990), but synthesis from macrophages migrating to the kidney during obstruction is another potential source of this vasoconstrictor (Schreiner et al, 1988; Harris et al, 1989).
Endothelin is another endogenous vasoconstrictor thought to participate in these events, although perhaps later in the established phase of UUO and after release of the obstruction. Administration of endothelin antagonists limits the reduction of RBF and GFR in rats during and after release of UUO (Bhangdia et al, 1998; Syed et al, 1998; Colon et al, 2000). Furthermore, endothelin excretion is increased in the targeted kidney after release of UUO in swine but not in the contralateral renal unit (Kelleher et al, 1992).
The kidney’s response to the release of UUO depends on the duration and extent of obstruction and is also species specific. Many models of UUO use complete obstruction of the ureter for 24 hours before release. After release of 24-hour UUO, the GFR is initially 50% of normal in dogs and less than 25% of normal in rats, accompanied by greatly reduced RBF. There are also regional differences within the kidney. Harris and Yarger (1974) showed a marked decrease in perfusion of the superficial cortex accompanied by an increase in juxtamedullary glomerular perfusion after release of 24 hours of UUO in rats. Tubuloglomerular feedback may play a role in these responses (Tanner, 1985). Some of the mediators of the hemodynamic changes in the kidney following release of the obstruction may be different from those involved in the earlier phases.
Hemodynamic Changes with Bilateral Ureteral Occlusion
The changes with BUO or obstruction of a solitary kidney are different. In contrast to the early robust renal vasodilation with UUO, there is a modest increase in RBF with BUO that lasts approximately 90 minutes, followed by a prolonged and profound decrease in RBF that is greater than found with UUO (Gulmi et al, 1995). Reyes and Klahr (1992) found that an NO synthesis antagonist caused a further decline in RBF and GFR compared with control values, suggesting that NO helps maintain renal hemodynamics in early BUO. Other potential vasodilators, such as platelet-activating factor (PAF), have been postulated to contribute to renal hemodynamic changes with BUO. Reyes and Klahr (1991) showed, in rats, that when vasoconstrictors such as TXA2 were blocked, endogenous or exogenous intrarenal PAF-mediated vasodilation contributed to the preservation of RBF and GFR. The earlier and more profound decrease in RBF with BUO may be contributed to by increased renal nerve stimulation that initiates vasoconstriction related to increased renorenal reflex activity (Francisco et al, 1980; Ma et al, 2002). Endothelin may also contribute to these responses in BUO. The administration of an endothelin antibody to rats with BUO was reported to attenuate the decreases in GFR and RPF (Reyes and Klahr, 1992). Angiotensin II and TXA2 are also probably involved in the changes occurring with BUO. The administration of inhibitors of either of these vasoconstrictors to rats, prior to BUO, resulted in improved postobstructive GFR and RPF compared with their administration at the time of release of obstruction (Purkerson and Klahr, 1989).
The intrarenal distribution of blood flow is quite different with BUO than with models of UUO. Jaenike (1972) used microspheres to show that 55% of the RBF perfused the cortical nephrons, while the innermost zones received only 14% of the flow in rats after BUO. Similarly, Solez and associates (1976) showed a 92% decrease in inner medullary plasma flow with 18 hours of BUO in rats. Thus the shift seen with UUO of blood flow from outer to inner cortex is the opposite of that with BUO.
Ureteral pressure is higher with BUO than with UUO. Although in both cases ureteral and tubular pressures are increased for the first 4 to 5 hours, the ureteral pressure remains elevated for at least 24 hours with BUO, whereas it begins to decline and approaches preocclusion pressures by 24 hours with UUO. The prolonged elevation in intratubular pressure contributes to the profound decrease in SNGFR and whole kidney GFR. Micropuncture studies (Yarger et al, 1972; Dal Canton et al, 1980) in which intratubular pressure is measured directly have demonstrated that it remains elevated in rats after 24 hours of BUO in comparison with pressure normalization in animals after 24 hours of UUO. Ureteral pressure remains high because BUO passes through a phase of preglomerular vasodilation and then a prolonged postglomerular vasoconstriction. This explains the persistent elevation in ureteral pressure in spite of a decrease in RBF and increase in renal resistance. In contrast, in UUO the initial preglomerular dilation and short-lived postglomerular vasoconstriction are followed by a more prolonged preglomerular vasoconstriction that tempers elevations in PGC and hence in PT. This difference between the two pathophysiologic conditions has been hypothesized to be due to an accumulation of vasoactive substances in BUO that could contribute to preglomerular vasodilation and postglomerular vasoconstriction. Such substances would not accumulate in UUO because they would be excreted by the contralateral kidney. Atrial natriuretic peptide (ANP) appears to be one of these substances (Purkerson et al, 1989). With excretory ability abrogated, BUO increases intravascular volume, as evidenced by an increase in pulmonary capillary wedge pressure and body weight, which serves as the stimulus for secretion of ANP. ANP increases afferent arteriolar dilation and efferent arteriolar vasoconstriction, thus increasing PGC. It also decreases the sensitivity of tubuloglomerular feedback, inhibits release of renin, and increases Kf (Fried et al, 1987; Brenner et al, 1990; Cogan, 1990). In addition, changes within the renal unit may contribute to elevated pelvic pressure. In both rats and humans, ureteral obstruction increases COX-2 in the proximal dilated ureter but not in the distal nondilated ureter. When the obstruction was released, the urinary concentration of PGE2 was elevated. Furthermore, a COX-2 selective inhibitor reduced pelvic pressure. Thus intrarenal PGE2 acting on ureteral smooth muscle may contribute directly to increased pelvic pressure after obstruction (Nørregaard et al, 2006). Glomerular filtration and RBF remain depressed after release of BUO. This is due to persistent vasoconstriction of the afferent arteriole (Jaenike, 1972; Moody et al, 1977). The decrease in RBF in the renal medulla remains more prominent than in the cortex (Solez et al, 1976). Tubuloglomerular feedback does not appear to contribute to this response as it does with UUO (Tanner, 1985). Urine flow and sodium excretion are increased after release of BUO. ANP appears to play a prominent role in this response based on its natriuretic properties and those previously reviewed. It may also have a protective effect. Ryndin and associates (2005) reported that the administration of ANP or phosphoramidon, an inhibitor of ANP degradation, to rats with BUO resulted in improved GFR and a more brisk diuresis and natriuresis after release of obstruction.
In summary, both UUO and BUO involve increases in renal vascular resistances and increases in ureteral pressures. However, the timing and regulation of these changes differ (Fig. 40–2). With UUO, early renal vasodilation primarily mediated by prostaglandins and NO is followed by prolonged vasoconstriction and normalization of intratubular-ureteral pressure as the contralateral kidney contributes to fluid balance. With BUO, little early vasodilation is seen, and vasoconstriction is more profound. When the obstruction is released, the postobstructive diuresis is much greater with BUO because volume expansion, urea and other osmolytes, and secreted ANP contribute to a profound diuresis and natriuresis.

Figure 40–2 Summary of the functional changes during and following ureteral obstruction. Symbols and abbreviations indicate ↑↓, increases and decreases; ~, little change; angII, angiotensin II; ANP, atrial natriuretic peptide; AQP, aquaporin; ECV, extracellular volume; ET, endothelin; FE, fractional excretion; NO, nitric oxide; PGC, glomerular capillary hydraulic pressure; PT, proximal tubular hydraulic pressure; PGE2, prostaglandin E2; Raff, afferent arteriolar resistance; Reff, efferent arteriolar resistance; RBF, renal blood flow; TG feedback, tubuloglomerular feedback; TXA2, thromboxane A2.
Partial Ureteral Occlusion
Although most models of urinary tract obstruction study complete obstruction over a fixed time interval, such as 24 hours, many clinical conditions involve partial obstruction over varying times. Partial obstruction models often involve perinatal obstruction where renal growth and differentiation may be affected, as well as hemodynamics and excretion. In many cases, the changes in renal hemodynamics and in tubular function are similar to those induced by more acute, complete models of obstruction but develop more slowly. In other cases, such as perinatal models of obstruction either before or shortly after birth, an animal such as a rat is still in a period of nephrogenesis. Consequently, formation of glomeruli and tubules may be compromised so that irreversible changes occur without total loss of kidney function.
Recovery of renal function in adult animals with partial obstruction has been studied as a potential guideline for clinical treatment. Leahy and coworkers (1989) studied dogs in which partial UUO with stents was studied for up to 60 days. Reversibility of renal function was estimated by creatinine clearance. Renal function became normal in dogs partially obstructed for 14 days. Animals partially obstructed for 28 days recovered 31% of function, and those partially obstructed for 60 days recovered only 8% of function. Casts of the microvasculature showed arteriolar constriction, supporting the concept that postobstructive renal dysfunction is influenced by vascular responses.
Much less is known about the roles of vasoactive or inflammatory mediators in the partial ureteral obstruction model. As with acute occlusive models, administration of indomethacin or meclofenamate, both prostaglandin synthetase inhibitors, decreases GFR and increases arteriolar resistance (Ichikawa and Brenner, 1979) so that changes in eicosanoids are implicated in partial obstruction responses. Several investigators have shown that the renin-angiotensin-aldosterone axis is activated with partial obstruction, including studies in the fetus. Gobet and colleagues (1999) studied fetal sheep in utero and showed that partial obstruction of the bladder outlet increased renin messenger RNA (mRNA) after 2 weeks and increased the expression of renal AT2 receptors as well as the mRNA for transforming growth factor beta (TGF-β), a mediator of fibrosis.
One could hypothesize that changes in angiotensin II may be responsible for much of the hemodynamic, fibrotic, and apoptotic changes in neonatal animals with partial obstruction, as has been shown in more acute models. Beharrie and coworkers (2004) examined weanling male rats that had been subjected to a partial UUO. The partial obstruction led to proteinuria, hyperuricemia, and increased solute excretion primarily from the unaffected contralateral kidney. A parallel group of rats treated with the ACE inhibitor enalapril was protected from these changes. This suggests that angiotensin is involved with functional tubular changes as well. Eskild-Jensen and colleagues (2002) examined partial UUO for up to 24 weeks in young, postnatal pigs. The number of glomeruli was 28% less in the obstructed kidney, yet function was just transiently reduced by the occlusion. Thus partial neonatal obstruction can impair nephrogenesis independently of renal functional decline, and these changes may depend upon species, stage of renal development, or degree of occlusion. More work is needed to define the variables.
Various methods have been used to create partial obstruction. The models for preparing partial ureteral occlusions fall into three main categories. Intraluminal stents or catheters of varying sizes have been placed in the ureters of sheep (Abu-Zidan et al, 1999) and in dogs (Ryan and Fitzpatrick, 1987; Leahy et al, 1989) to restrict flow. In rats, or in growing animals, many investigators have used the technique of Ulm and Miller (1962), which involves splitting the psoas muscle longitudinally to form a groove into which the ureter is placed. This method has a potential advantage of increased constriction in proportion to the growth of the animal. Beharrie and colleagues (2004) used such a technique in young male weanling rats. A major problem with studies involving partial obstruction is the inability to determine reproducibly and accurately the degree of obstruction induced with these techniques. Thornhill and associates (2005) devised a method in neonatal rat pups of ligating a ureter along with a wire of a calibrated diameter that was then removed to make a partial and graded constriction of one ureter. When ureteral diameter was reduced by 70% to 75%, renal growth and number of glomeruli were reduced and fibrosis and pelvic dilation were proportionately increased. GFR was reduced by 80% after 28 days of partial UUO. Such models may offer new opportunities to model the clinical condition reproducibly.
Egress of Urine from the Kidney
Although the normal flow of urine from the kidney through the urinary tract is compromised with obstruction, urine may still egress from the kidney. An example of this is extravasation at the calyceal fornix (pyelosinus) that occurs with acute obstruction, typically ureteral stones (Stenberg et al, 1988). Extravasation of urine into the venous (pyelovenous) and lymphatic system (pyelolymphatic) may also occur in this setting. In chronic obstruction, fluid is thought to exit into the renal venous system.
Effects of Obstruction on Tubular Function
Obstruction of one or both kidneys can have profound effects on sodium, potassium, and hydrogen excretion and mechanisms of urinary concentration and dilution. In the case of UUO, relatively normal function of the nonobstructed kidney partially offsets the reduced ability of the postobstructive kidney to reabsorb solutes and water. Postobstructive diuresis, something that is commonly encountered after reversal of BUO, occurs uncommonly after release of UUO, probably as a consequence of the contralateral renal unit’s functional capacities that are enhanced by an upregulation of ion transporters (Li et al, 2007). The eventual correction of abnormal renal excretory function depends upon the degree and duration of obstruction.
Changes in tubule function after correction of UUO related to ureteropelvic junction or ureteral obstruction were characterized in 10 patients by Gillenwater and colleagues (1975). The mean period of obstruction in these cases was 12 months, and the range was from days to years. Functions of the normal and obstructed kidney were evaluated 1 week after relief of the obstruction. The GFR in the obstructed kidney was significantly less than that in the non-obstructed kidney (24 vs. 60 mL/min), and the urine osmolality and osmolar clearance were all significantly less in the postobstructed kidney. The similar osmolar clearances (volume of urine required to excrete urinary solute isosmotically) relative to GFR of the previously obstructed and unobstructed kidneys indicate that there is a true concentrating defect in the obstructed kidneys 1 week after relief of obstruction.
Urinary Concentrating Ability
Normal urine concentrating ability requires a hypertonic medullary interstitial gradient because of active salt reabsorption from the thick ascending limb of Henle, urea back flux from the inner medullary collecting duct, and water permeability of the collecting duct mediated by vasopressin and aquaporin water channels. Obstructive nephropathy can disrupt some or all of these mechanisms and lead to deficits in urinary concentration. A brief review of the normal concentrating mechanisms is provided to facilitate understanding the effects of obstruction.
In normal physiology, arginine vasopressin (AVP) is secreted into the bloodstream from the posterior pituitary gland in response to increased serum osmolality or a reduction in effective circulating volume. AVP binds to the V2 vasopressin receptor located on the basolateral surfaces of the collecting duct cells. This promotes G protein signaling, resulting in generation of cyclic adenosine monophosphate (cAMP). Generation of cAMP in turn activates protein kinase A, which stimulates the fusion of cytoplasmic vesicles containing aquaporin 2 (AQP2) with the apical membranes of the collecting duct cells. The fusion causes the normally watertight membrane to become water permeable. This promotes transcellular absorption of water through the AQP2 channels, which is transported through aquaporin 3 (AQP3) and aquaporin 4 (AQP4) channels located in the basolateral cell membrane into the interstitium. This sequence of events is driven by the osmotic gradient of sodium (Knoers, 2005). Another aquaporin, aquaporin 1 (AQP1), is abundant in renal proximal tubules, the thin descending limb of Henle, and the descending vasa recta in the kidney. It promotes urinary concentration through the countercurrent multiplier by facilitating water transport from the descending limb of Henle into the interstitium (King et al, 2001).
The onset of concentration defects may develop soon after obstruction. Jaenike and Bray (1960) demonstrated a concentrating defect in the unilaterally obstructed kidney after only 6 minutes of ureteral obstruction. Development of vasopressin resistance has been hypothesized as a mechanism of this occurrence. However, various studies have demonstrated conflicting results concerning whether vasopressin resistance is present. Vascular changes may play a role. Even after only 18 hours of UUO, Solez and colleagues (1976) found a decrease in inner medullary plasma flow that increased when the occlusion was released. Necrosis of both the inner and outer medullae was present, indicating that ischemia may contribute to the development of a concentrating defect.
Evidence from Li and coworkers (2001) demonstrated that the polyuria following the release of BUO correlates with a decreased expression of the aquaporin water channels AQP1, AQP2, and AQP3 in rats. Release of obstruction resulted in polyuria that gradually decreased over a 30-day period, even though urinary concentrating capacity remained significantly impaired. Expression of AQP2 and AQP3 became normal by 30 days after release, but the expression of AQP1 remained decreased.
Jensen and coworkers (2006) examined changes in water channels after bilateral ureteral obstruction in rats. As expected, postobstructive polyuria with reduced urine osmolality was accompanied by decreased expressions of AQP1, AQP2, and AQP3 compared with control rats. The AT1 antagonist candesartan attenuated reductions in GFR, urine output, and AQP suppression, as well as COX-2 induction in the inner medulla. These findings suggest that angiotensin II influences, directly or indirectly, the postobstructive diuresis of BUO.
Thus dysregulation of aquaporin water channels in the proximal tubule, thin descending loop, and collecting duct may contribute to the long-term polyuria and impaired concentrating capacity caused by obstructive nephropathy. Increases in angiotensin II may be a mediator of these changes.
Sodium Transport
A decrease in sodium transport in the nephron appears to play an additional prominent role in the decreased ability of the postobstructed kidney to concentrate urine. When UUO is released after an occlusion period of 24 hours, total urine excretion is normal to modestly increased despite increased fractional excretion of sodium (FENa) in the previously obstructed kidney. This is attributed to the contralateral kidney compensating for the sodium losses of its mate. However, with BUO, sodium and water excretions may be quite robust after release of obstruction. The FENa may be increased to as much as 20 times normal in this setting (Zeidel and Pirtskhalaishvili, 2004). Although ANP appears to play a role in sodium diuresis after release of BUO, it is unlikely to affect sodium transport defects associated with UUO. The latter is most likely due to selective cell membrane changes in the nephron that reduce the number and effectiveness of sodium transporters. Such changes may also occur with BUO.
In spite of differential quantitative responses between UUO and BUO after release of the obstruction, the reabsorption defects in segmental nephron Na+ transport are similar. Micropuncture studies of kidneys from animals have been undertaken to assess these responses. These studies demonstrate normal to modestly enhanced isotonic volume flux (Jv) in superficial proximal convoluted tubules after release of UUO or BUO. On the other hand, sodium delivery to the loop of Henle in juxtamedullary nephrons, and to the first accessible portion of the inner medullary collecting duct, is substantially increased after release of both UUO and BUO, indicative of reduced sodium transport. Sonnenberg and Wilson (1976) even found evidence for net influx of sodium throughout the medullary collecting duct, which further contributed to an increased FENa. However, this was more prominent with BUO in their rat model.
Studies in isolated perfused nephron segments have also provided knowledge about the impact of obstruction at the level of the nephron. They have shown normal isotonic reabsorption in the superficial proximal convoluted tubules from animals with either UUO or BUO, whereas Jv in proximal straight tubules from juxtamedullary nephrons was demonstrated to be impaired (Hanley and Davidson, 1982). Similarly, chloride reabsorption and transport-dependent oxygen consumption (QO2) from the medullary thick ascending limb of the Henle loop (MTAL) were severely impaired (Hanley and Davidson, 1982; Hwang et al, 1993b).
Cell suspensions from nephron segments have been used to assess the effects of obstruction at a cellular level. Active transport of Na+ across cell membranes requires apical entry through selective Na+ transporters or channels and basolateral exit driven by sodium-potassium adenosine triphosphatase (Na+,K+-ATPase). Furthermore, adequate adenosine triphosphate (ATP) must be generated to drive these primary transport steps. Hwang and associates showed that the amount and activity of the apical Na+,K+,2Cl− cotransporter and bumetanide binding sites were reduced in cells isolated from the MTAL derived from obstructed rabbit kidneys. Basolateral transport is also affected in that ouabain-sensitive oxygen consumption, an index of Na+,K+-ATPase activity, has been shown to be reduced in cell suspensions from obstructed kidneys (Hwang et al, 1993a). A marked decrease in amiloride-sensitive oxygen consumption and Na+ entry in isolated cells from the inner medullary collecting ducts of obstructed rabbit kidneys reflects reduced activity of the apical Na channel (ENaC). In addition, ouabain-sensitive transport as measured by oxygen consumption and ATPase activity was shown to be reduced in cells from this portion of the nephron harvested from obstructed kidneys (Hwang et al, 1993a). Because cell suspension studies indicate that ATP generation is not the rate-limiting step underlying sodium transport dysfunction in this setting, the evidence points to downregulation of sodium transporters. This may be due to translational factors (reduction in mRNA for transporter synthesis) or post-translational processing of receptor proteins (Hwang et al, 1993a).
The signals responsible for downregulation of transporter activity with obstruction have not been clearly defined, but a number have been hypothesized. Stasis of tubular fluid flow may be one of the signals. When urine flow is obstructed, upstream Na+ delivery to apical cell membranes slows so that the transmembrane gradient is reduced. This could then serve as the signal for the downregulation of transporter activity or expression resulting in reduced active Na+ transport across the basolateral cell membrane (Zeidel, 1993). Several studies indicate that this is a feasible mechanism. For example, ouabain-sensitive Na+,K+-ATPase activity is reduced in MTAL and collecting duct cells when mineralocorticoid activity is controlled and chronic furosemide or amiloride is given to reduce Na+ entry into tubule cells (Petty et al, 1981; Grossman and Hebert, 1988). Additional studies have explored this concept in established cell lines. When A6 cells, an established line of collecting duct cells, are grown on a permeable substrate, Na+ influx across the apical membrane through the ENaC Na+ channel occurs. When Na+ entry was blocked, this induced a decreased expression of β-subunit of the epithelial sodium channel in the apical membrane (Rokaw et al, 1996). Ischemia has also been proposed as a signal in this setting, where ischemia that accompanies the reduced perfusion of the kidney with obstruction can also be a mediator of reduced transporter expression. The reduction in major renal sodium transporters reported with ischemic models of renal failure supports this concept (Kwon et al, 2000). Other proposed downstream signals include changes in renal interstitial pressure and local generation of natriuretic substances. Thus substrate delivery may be a regulatory step in the expression of sodium and possibly other transporters.
Intrarenal and extrarenal substances and hormones can also modulate sodium transport. The milieu of influential hormones may be substantially different between UUO and BUO. A number of investigators have shown that obstruction markedly increases the endogenous production of PGE2 in the renal medulla. Furthermore, supraphysiologic concentrations of PGE2 are well known to produce natriuresis (Strandhoy et al, 1974), and studies in isolated tubules and cell suspensions show that PGE2 inhibits Na reabsorption in the MTAL and throughout the collecting duct (CD). One mechanism of this natriuretic response may be that PGE2 reduces the amount of Na+,K+-ATPase at the basolateral membrane (Marver and Bernabe, 1992). PGE2 can also inhibit the tubular effects of vasopressin (Zook and Strandhoy, 1980), thereby contributing to the free water loss from the post-UUO kidney. The influence of other substances and hormones in the postobstructed UUO kidney is counterbalanced or minimized by the contralateral renal unit.
Li and coworkers (2007) found that BUO caused a persistent decrease in the alpha and beta subunits of the epithelial Na channel (ENaC) three days after relief of obstruction. Similar changes in ENaC occurred following UUO but only in the obstructed kidney. The contralateral control kidney showed no changes in ENaC expression. Furthermore, Jensen and coworkers (2006) showed in rats that at 2 days following BUO there was reduced expressions of the Na phosphate cotransporter (NaPi-2), the loop Na+,K,2Cl− cotransporter (NKCC2) and the Na+/H+ exchanger (NHE3). These decreases in Na transporters were consistent with the postobstructive natriuresis. Candesartan partially reduced these changes and attenuated the natriuresis.
Extracellular fluid volume may be greatly expanded with BUO. When the BUO is relieved, both intrarenal and extrarenal factors greatly enhance salt and water excretion so that a postobstructive diuresis is often seen. The normal physiologic consequences of extracellular fluid volume expansion ensue. These include a downregulation of sympathetic tone and the secretion of aldosterone and manifestation of the effects of ANP and probably other natriuretic factors. Levels of ANP are significantly elevated following BUO but not UUO (Purkerson and Klahr, 1989). The direct and indirect consequences of increased ANP levels include partial support of glomerular filtration, reduction of renin secretion and effects of angiotensin on transport, reduced aldosterone secretion, and direct inhibition of Na transport in the collecting duct (Brenner et al, 1990). Furthermore, BUO results in the accumulation of osmotic substances such as urea that can contribute to salt and water loss when the obstruction is relieved (Harris and Yarger, 1975, 1977). The FENa following relief of BUO is typically greater than that after UUO because BUO causes retention of Na, water, urea nitrogen, and other osmolar substances and increased production of ANP, all of which stimulate a profound natriuresis. Although Na transporters are similarly downregulated in the affected kidney in UUO, the contralateral kidney adequately compensates to maintain Na balance.
Potassium Transport
Obstruction has a complex impact on renal potassium handling, depending upon the type of obstruction. Harris and Yarger (1975) reported that there is a decrease in K+ excretion, in proportion to the decrease in GFR, after release of a 24-hour period of UUO. This may be partially due to reduced delivery of Na+ to the distal nephron and a low volume flow rate that would minimize the transmembrane gradient for K+ secretion. Other investigations indicate that there is also an intrinsic defect in K+ secretion after relief of UUO (Thirakomen et al, 1976). In contrast, K+ excretion increases in parallel with Na+ excretion with the relief of BUO. Micropuncture studies in rats showed that proximal reabsorption of K+ remains unchanged, whereas secretion in the collecting duct is increased following release of BUO. This may be due to the massive increases in Na+ and water delivery to the collecting duct acting as stimuli to secretion and also to the presence of high levels of ANP that can stimulate K+ secretion in the distal nephron (Sonnenberg and Wilson, 1976).
Hydrogen Ion Transport and Urinary Acidification
Obstruction causes a deficit in urinary acidification that has been demonstrated in human subjects as well as animal models. The cumulative evidence indicates that the major acidification defect is in the distal nephron. Release of obstruction does not result in increased bicarbonate excretion, indicating that bicarbonate reclamation in the proximal tubule remains intact. In contrast, urinary pH does not decrease after an acid load, which is indicative of a distal nephron acidification defect, most likely related to defective H+ transport in the collecting duct. A number of causes for the lack of acidification have been proposed, including defects in H+-ATPase or H+,K+-ATPase, Cl−/HCO3− exchange, a back leak of protons into the renal interstitium, or failure to generate a satisfactory transluminal electrical gradient. Obstruction has been demonstrated to decrease the expression of H+-ATPase in the apical membrane of the intercalated cells of the collecting duct. However, the extent of this apical transporter decrease was too small to explain the significant acidification defects that develop. Therefore other mechanisms are also likely to play a role in the development of this acidification defect (Purcell et al, 1991). Valles and Manucha (2000) showed that the decrease in H+-ATPase with UUO depends upon an increase in iNOS, which, in turn, appears to be regulated by angiotensin II. Thus recovery of H+-ATPase activity in the inner medullary collecting duct of obstructed kidneys by losartan treatment may be related to a decrease in angiotensin-stimulated iNOS activity.
Wang and colleagues (2008b) showed that the urinary acidification defect and metabolic acidosis after release of BUO correlated with reduced expression of the Na+/H+ exchanger (NHE3) in the cortex, reduced electrogenic Na+/HCO3− cotransporter (NBC1), the electroneutral Na+/HCO3− cotransporter (NBCn1) and the anion exchanger, pendrin. These findings support alterations in both proton secretion and bicarbonate/anion transport in the acid-base defects found after the release of obstruction.
In the proximal tubule, glutamine uptake and oxidation and ammonia generation are diminished after release of obstruction. This has an impact on acid elimination in that a greater proportion of H+ is buffered as titratable acid. Because phosphate excretion may be compromised, and binding of protons to phosphate has a limited capacity, the net result may be a lower urinary pH related to unbuffered protons, in spite of a net decrease in total H+ secretion.
Effects of Obstruction on Anion and Other Cation Transport
The effects on phosphate reabsorption after the release of obstruction vary depending upon whether it was bilateral or unilateral. When BUO is released, accumulated phosphate is rapidly excreted in proportion to sodium (Beck, 1979). Conversely, a decrease in phosphate excretion and a net retention occur with release of UUO. Weinreb and colleagues (1982) showed that the decrease in the fractional excretion of phosphate following release of UUO in dogs produced no change in the transport of phosphate across brush border membrane vesicles. A reduced filtered load in the previously obstructed renal unit may stimulate increased phosphate reabsorption. Westenfelder and coauthors (1998) reported findings supporting the latter. They demonstrated that the increased reabsorption of phosphate after release of UUO in rats is due to a generalized increase in proximal tubular sodium reabsorption, a process linked to a reduction in GFR. They noted that this was linked to increased cotransport of phosphate and glucose with sodium.
Excretion of other cations is also induced by obstruction. Magnesium excretion is markedly increased after the release of either UUO or BUO. The increase most likely results from compromised transport in the thick limb of the Henle loop, which is related to ischemia. This causes decreased influx of Na+, K+, and Cl− by the cotransporter and reduced back flux of K+ across the apical membrane. It attenuates the positive luminal transepithelial voltage that normally drives the paracellular flux of both magnesium and calcium from lumen to basolateral membrane. The result is reduced passive reabsorption of Mg2+ and Ca2+ from the loop of Henle. However, calcium excretion may be increased or decreased, depending to a degree on the type of obstruction and the species. Although Mg2+ and Ca2+ are handled similarly in the thick limb of the Henle loop, calcium handling in the early distal tubule differs. Beaumont and coworkers (1989) demonstrated that the thiazide-inhibitable sodium chloride cotransporter is rapidly downregulated during ischemia, such as may accompany ureteral occlusion. Blocking influx of Na+ and Cl− through this transporter hyperpolarizes the cells in the distal nephron, thereby increasing calcium reabsorption (Gesek and Friedman, 1992). Thus disruption of transport in areas of the nephron where Ca2+ and Mg2+ are differentially transported may account for varying effects of obstruction on their net transport and excretion.
Organic anions and cations are transported by the renal tubules as substrates of metabolism and as a mechanism of drug elimination. In rats, BUO decreases the renal clearance of p-aminohippurate (PAH), a prototypical substrate for the organic anion transporter 1 (OAT-1). Although secretion of PAH was reduced, the reduction did not correlate with a decrease in OAT-1 abundance or with cortical blood flow. It is postulated that decreased Na+,K+-ATPase activity, which provides the primary active transport to which OAT-1 is coupled, explains the decrease in PAH transport. In addition to the implications for drug transport and excretion with obstruction, this indicates that PAH clearance without measurement of extraction is an inaccurate index of RPF in postobstructed kidneys (Villar et al, 2004).
Effect of Obstruction on the Excretion of Peptides and Proteins
Some peptides and small proteins are normally filtered by the glomerulus and readily absorbed in the nephron. Some enzymes and proteins, such as Tamm-Horsfall protein and aquaporins, may normally be secreted into the tubular fluid. Obstruction can exaggerate or disrupt the excretion of these proteins and peptides. Some changes simply represent alterations in transport, whereas others are due to tubular damage and remodeling.
Monocyte chemoattractant protein 1 is a mediator of the inflammatory process accompanying obstruction in the kidney. Its excretion in the urine after UUO increases (Stephan et al, 2002) and has been considered an index of tubular damage. Conversely, epidermal growth factor (EGF) excretion, the renal cortical and outer medullary concentration of pre-pro-EGF, and excretion of Tamm-Horsfall protein (Storch et al, 1992) all decrease with obstruction. Urinary enzymes thought to be derived from the proximal tubule, such as alkaline phosphatase, γ-glutamyltransferase, N-acetyl-β-D-glucosaminidase, and leucine aminopeptidase have been reported to be elevated in patients with obstructed kidneys (Carr et al, 1994). However, such increases in enzymuria have been reported to be either biphasic, occurring only in the early stages of obstruction, or absent in animal models of partial or total ureteral obstruction (Everaert et al, 1998).
In summary, major changes occur with the ability of the kidney to concentrate the urine because of the downregulation of transporters and aquaporin water channels. These defects are enduring and correct slowly with time. Sodium excretion is greater after relief of BUO because extracellular volume is expanded and ANP directly affects transport and glomerular filtration. Potassium and phosphate excretions follow changes in sodium; they are decreased with UUO because of altered transporters and postobstructive retention and increased transiently with BUO in parallel with the massive natriuresis. Obstruction causes a deficit in urinary acidification that has been demonstrated both in humans and in animals. Magnesium excretion is increased in both models, but calcium handling is more complex. Changes in peptide excretion reflect mediators and markers of renal damage.
Metabolic Determinants of Ion Transport
An overview of the normal metabolic processes linked to ion transport provides a foundation for the understanding of changes that occur with obstruction. The myriad of transporters involved in maintaining cellular homeostasis and electrolyte balance is integrated longitudinally and vertically within the nephron. Families of ion-translocating ATPases mediate primary and secondary transport and are fueled by the availability and synthesis of ATP. In addition to providing energy for ion pumps, the adenine nucleotides can directly influence ATP-sensitive K+ channels that link the activity of the sodium pump with the leak of potassium in some of the nephron segments, such as the thick ascending limb of the Henle loop and the collecting duct.
Although there is considerable variability between nephron segments, and even between species in the normal physiologic substrate for ATP generation in nephron segments, a few generalizations can be made. Aerobic glycolysis in several cell types, including renal tubules, links ATP generation to increased activity of Na+,K+-ATPase, QO2, cAMP, and primary active transport of ions. In normal physiology, the renal cortex has a high rate of aerobic metabolism indicative of fatty acid oxidation and a low content of glycogen. Proximal tubules have relatively little glycolytic capacity and depend upon aerobic mitochondrial metabolism for ATP synthesis from substrates such as ketone bodies, fatty acids, glutamine, and lactate (Uchida and Endou, 1988; Ruegg and Mandel, 1990). Metabolism even varies along the length of the proximal tubule. For example, the proximal convoluted tubule cannot use glucose to support oxidative metabolism, but the proximal straight tubules can.
The medullary and cortical regions of the thick ascending limb of the Henle loop possess abundant mitochondria and high QO2. Substantial energy reserves allow increased transport associated with glomerulotubular balance. This nephron segment and those downstream have the capability of aerobic and anaerobic glycolysis, which results in lactate accumulation and increased glycogen content (Abodeely and Lee, 1971; Cohen, 1979; Bagnasco et al, 1985). Compared with the proximal tubule, the medullary thick ascending loop of Henle has a greater capacity for anaerobic glycolysis but still requires ATP production from mitochondrial oxidative phosphorylation to maintain active Na+ transport.
In addition to its role as a fuel for metabolism and transport, ATP and its metabolites can serve as regulators of solute transport, such as the ATP-sensitive K+ channels previously mentioned, and activation of purinergic P2 receptors within the kidney that modulate solute transport (Schwiebert and Kishore, 2001).
Although substrate availability for energy production related to transport is not generally rate limiting under physiologic conditions (Guder and Schmidt, 1976), some parts of the kidney, such as the thick ascending limb of the Henle loop, are located in areas where there is a tenuous balance between oxygen supply and demand. Consequently, these parts of the nephron are more susceptible to hypoxic injury and associated transport dysfunction. Therefore in addition to downregulation of the transport proteins themselves, with obstruction, the energy sources for transport function are at risk.
Renal obstruction provokes a number of changes in the metabolic cascade. There is a shift from oxidative metabolism to anaerobic respiration. This shift results in a reduction of renal ATP levels, an increase in amounts of adenosine diphosphate (ADP) and adenosine monophosphate (AMP), and an increase in the renal lactate-to-pyruvate ratio (Stecker et al, 1971; Middleton et al, 1977; Nito et al, 1978; Klahr et al, 1986).
Cellular and Molecular Mechanisms Leading to Tubular Cell Death through Apoptosis
Renal obstruction produces tubular atrophy and cell death. The major mechanism by which tubular cells die is apoptosis, a process that is normally involved in postnatal development and tissue renewal in adults. The process can be triggered by both intrinsic and extrinsic factors and results in degradation and condensation of the nucleus. The cells are further degraded into apoptotic bodies, which are eventually phagocytized by healthy cells, usually without inducing inflammation. When rat kidneys are obstructed, renal tubular cell apoptosis begins in about 4 days and peaks after 15 days, with interstitial cell apoptosis continuing for the duration of obstruction (Choi et al, 2000). Glomerular cells appear to be resistant to obstruction-induced apoptosis. Pathological apoptosis of tubule cells from obstruction may secondarily trigger inflammatory responses from the release of cytokines and recruitment of leukocytes (Canbay et al, 2004).
Cysteinyl aspartate-specific proteinases (caspases) are known to mediate apoptotic cell death in obstructed kidneys (Hengartner, 2000; Truong et al, 2001). This family of 12 enzymes can be categorized into three main groups: initiators, effectors, and cytokine processors. Two distinct pathways of caspase activity are involved. One pathway involves activation of membrane death receptors by extrinsic binding of tumor necrosis factor alpha (TNF-α) to its receptor. A second pathway involves intrinsic stress signals that result in mitochondrial release of proapoptotic proteins such as cytochrome c. The two pathways converge to activate effector caspases, which cleave nuclear and cytoplasmic components, resulting in condensation of nuclear material and cell death. Truong and colleagues (2001) showed that all of the caspases increased with renal obstruction and that their levels paralleled renal cell apoptosis. Caspases 3 and 8 best correlated with renal cell apoptosis and appear to be central to this process (Choi et al, 2000; Truong et al, 2001).
In contrast to the defined role of angiotensin II in obstruction-induced renal fibrosis, its involvement in renal cell apoptosis is less clear. In mice with a knockout deletion of the AT2 receptor, there is a decreased degree of obstruction-induced apoptosis. However, these receptors are normally downregulated in the adult kidney, and their role in normal function and pathophysiologic responses is uncertain in the mature kidney. Angiotensin blockade or ACE inhibition has been shown by some investigators to reduce apoptosis in the early phases of renal obstruction (Truong et al, 1998; Eskild-Jensen et al, 2007), but others have reported conflicting results.
TNF-α can be a directly cytotoxic cytokine that can induce apoptosis in addition to its role in renal inflammation. When TNF-α binds to its receptor, TNFR1, an associated death domain (TRADD) binds to the TNFR1 and activates several signaling pathways. When coupled to a Fas-associated death domain, it triggers caspase 8 activation, which is pivotal to apoptosis. Alternatively, the TNFR1-TRADD complex can activate nuclear factor–κB (NFκB), which can have both pro- and antiapoptotic activity depending upon the cellular milieu. Increased amounts of TNF-α and its receptors have been demonstrated in rat models of obstruction (Tartaglia et al, 1991; Kaneto et al, 1996; Choi et al, 2000), along with other components of this cascade. These findings suggest an important role for TNF-α in apoptosis after obstruction.
Although the processes leading to renal apoptosis, inflammation, and fibrosis have many distinct pathways and mediators, they may also be intimately linked. Apoptosis is a primary cellular event leading to many toxic and ischemic insults. Although it is usually thought of as programmed cell death without inflammation, extensive damage to many cells may rupture and release cell contents and activate transcription factors, such as NFκB, to stimulate production of proinflammatory cytokines. Clearance of apoptotic debris through phagocytosis may directly stimulate fibrogenesis in many tissues, and fibrosis accompanying tissue injury may reciprocally induce pro-apoptotic gene expression such as the Fas/FasL pathway (Canbay et al, 2004).
Cellular and Molecular Changes Leading to Fibrosis
Urinary tract obstruction leads to progressive and, eventually, permanent changes in the structure of the kidney, including the development of tubulointerstitial fibrosis, tubular atrophy and apoptosis, and interstitial inflammation. A number of cytokines and growth factors have been shown to play roles in these events, among which the most prominent include transforming growth factor beta TGF-β, angiotensin II, NFκB, and TNF-α. Some are produced directly from the renal tubular and interstitial cells; others are generated from infiltrating macrophages.
Tubulointerstitial fibrosis develops as a consequence of extracellular matrix being synthesized and deposited at a greater rate than it is degraded, as well as to a relative increase in matrix due to collapse of parenchymal volume as nephrons are destroyed (Hewitson, 2009). A family of enzymes known as matrix metalloproteinases (MMPs), which includes collagenase, normally cleaves and degrades the collagenous and noncollagenous components of the extracellular matrix. Obstruction increases the synthesis of tissue inhibitors of metalloproteinases (TIMPs) that reduce MMP activity, resulting in the accumulation of extracellular matrix. Infiltrating macrophages stimulate TGF-β synthesis, and this growth factor increases TIMP production, thus reducing collagen turnover. Macrophages also produce other cytokines and growth factors, such as interleukin 2, interleukin 6, fibroblast growth factor, and platelet-derived growth factor (PDGF), that appear to contribute to this inflammatory and fibrotic process. Active TGF-β binds directly to its type 2 receptor, which subsequently activates and phosphorylates the type 1 TGF-β receptor. Both of these receptors have been shown to be upregulated in rats with UUO, in both the obstructed and contralateral renal units. This may be a factor in the hypertrophic response sometimes seen in the nonobstructed kidney (Sutaria et al, 1998). The activated type 1 TGF-β receptor subsequently phosphorylates SMAD (mobile transcription factors with a name derived from related genes in Caenorhabditis elegans [Sma] and Drosophila [Mad]) proteins. A heteromeric complex of SMAD proteins translocates to the nucleus, where it interacts with transcription factors to regulate gene transcription (Wamsley-Davis et al, 2004) and stimulates tubulointerstitial fibrosis (Fukasawa et al, 2004). Stimulation of TGF-β furthermore stimulates the JNK1 (c-JUN N-terminal protein kinase 1) pathway, which targets the activation of c-Jun and activates transcription factor 2, which are critical components in activating fibronectin production. Increased mRNA expression of TGF-β is seen as early as 10 hours after obstruction and increases for 4 days (Walton et al, 1992; Diamond et al, 1994). The increase occurs primarily in medullary tubules and the interstitium and is less prominent in cortical tubules or glomeruli. Furthermore, TGF-β interacts with other profibrotic growth factors such as EGF and angiotensin II (Kaneto et al, 1993; Ishidoya et al, 1995; Chevalier et al, 1998).
Angiotensin II upregulates the expression of TGF-β1 in UUO, whereas ACE inhibitors or angiotensin receptor blockers diminish TGF-β1 expression and reduce tubulointerstitial fibrosis. This effect, and increases in TNF-α and NFκB promoted by activation of the renin-angiotensin axis, underscore the importance of this system in the obstructive process. Angiotensin II exerts its biologic effect through both AT1 and AT2 receptors, although in adult mammals, the AT1 receptors predominate and account for most of the known effects of the peptide. With UUO, a significant rise in both renal angiotensin II content and AT1 receptor expression is found (Misseri et al, 2004). Nephron angiotensin receptors are found in areas of the kidney where the peptide is known to have its greatest biologic effect: the proximal tubule, the thick ascending limb of the Henle loop, and the glomerulus (Sechi et al, 1992; Meister et al, 1993). The importance of this pathway has been shown in a murine AT1α receptor knockout model in which the mice have significantly less collagen expression and deposition, interstitial volume, and extent of obstruction-induced renal fibrosis (Morrissey and Klahr, 1998a). Angiotensin II stimulates cytosolic and mitochondrial oxidant production, which eventually leads to mitochondrial dysfunction. Activation of integrin signaling, release of TGF-β1 and transcription factor NFκB leads to a cell-type transition from epithelium to mesenchymal myofibroblasts that synthesize extracellular matrix (de Cavanagh et al, 2009). Angiotensin II activates the transcription factor NFκB, which, in turn, increases the expression of several chemokines and cytokines involved with the fibrotic process. The NFκB also upregulates the expression of the angiotensinogen gene and thereby provides a positive feedback for further angiotensin II production (Morrissey and Klahr, 1998b). The intimate link between angiotensin and NFκB was demonstrated in a study in which enalapril, an ACE inhibitor, reduced the levels of NFκB and fibrosis in a model of renal obstruction (Morrissey and Klahr, 1997).
The release of TNF-α, a potent inflammatory cytokine, is also stimulated by angiotensin, especially in the first few hours of renal obstruction. It can upregulate its own expression as well as that of other inflammatory mediators such as interleukin 1, PAF, NO, eicosanoids, and cell adhesion molecules. Although macrophages are a major source of TNF-α, renal tubular cells are also capable of producing it and become the predominant source of TNF-α after renal injury. Its role in renal inflammation and fibrosis is supported by studies in mice with knockout deletions of the two types of TNF receptors having less fibrosis.
Although the events leading to fibrosis are thought to be initiated by increased angiotensin II, other profibrotic factors appear to play a significant role because inhibition of angiotensin synthesis by ACE inhibitors or antagonism of the AT1 receptors blunts but does not completely abolish the fibrotic process (Kaneto et al, 1993; Ishidoya et al, 1995; Pimental et al, 1995).
In summary, obstruction of normal urine outflow results in biochemical, immunologic, hemodynamic, and functional changes. It stimulates a cascade in which elevated levels of angiotensin II, cytokines, and growth factors lead to tubular cell apoptosis and cellular inflammation, increased net matrix formation, and tubulointerstitial fibrosis. Many of the mediators are intrinsic to the renal tubular cells, whereas others are contributed by fibroblasts and by migrating macrophages (Fig. 40–3).

Figure 40–3 Summary of major pathways leading to tubulointerstitial fibrosis and tubular apoptosis as a consequence of ureteral obstruction. Membrane proteins and regulators are discussed in the text. ang II, angiotensin II; HGF, human growth factor; HSPs, heat shock proteins; IGF, insulin-like growth factor; JAK/STAT, Janus kinase/signal transducers and activators of transcription; mφ, macrophages; MAP, mitogen-activated protein; NF-κB, nuclear factor κB; TGF, transforming growth factor; TNF, tumor necrosis factor; TNFR1, tumor necrosis factor receptor 1.
Experimental Treatment Approaches to Attenuate Renal Fibrosis and Functional Impairment
The aforementioned cascade of events points to many possible avenues to attenuate renal damage associated with obstruction. Experimental strategies to attenuate these noxious responses are reviewed.
Angiotensin antagonism is the best-studied therapeutic approach due to the clear link between angiotensin and renal injury and the clinical availability of ACE inhibitors and angiotensin receptor blockers (ARBs). Wamsley-Davis and colleagues (2004) administered the ACE inhibitor enalapril, the AT1 antagonists losartan or candesartan, or vehicle for up to 52 days to male rats with UUO. Candesartan inhibited the rise in JNK1 activity, losartan attenuated it, and enalapril did not affect it. Candesartan also reduced SMAD2 protein activation while attenuating the chronic tubulointerstitial fibrotic injury in obstructed kidneys and preserved renal mass. The apparent differences between candesartan, losartan, and enalapril may be dose- or delivery-related in that the AT1 antagonists were continuously infused by mini-pumps, whereas enalapril was added to the drinking water, and dose-response relationships were not examined. Manucha and colleagues (2005) showed, in rats, that losartan attenuated fibrosis in unilaterally obstructed kidneys by reducing oxidative stress as measured by lowered hydroxyl and oxygen radicals and increased superoxide dismutase and heat shock protein 70 levels.
In addition to the clear importance of angiotensin II in the processes leading to fibrosis and possibly apoptosis, other peptides in this family may be involved. Ureteral obstruction not only increases angiotensin-converting enzyme (ACE) and angiotensin II, but also decreases ACE-2, the enzyme most responsible for production of angiotensin-(1-7) (Bae et al, 2007). Angiotensin II stimulates many kinases probably involved in the profibrotic process, while angiotensin-(1-7) stimulates phosphatases that antagonize these effects (Gallagher et al, 2006). Inhibiting ACE shunts peptide production from angiotensin II towards more synthesis of angiotensin-(1-7). Thus the beneficial effects of ACE inhibitors and angiotensin receptor blockers may reside both in the synthesis and effect of less angiotensin II and the increased effect of angiotensin-(1-7). If so, the use of the latter as a drug could be explored, or there may be other means to modulate intrarenal kinases and phosphatases.
Manucha and colleagues (2004) showed that losartan prevented the development of renal fibrosis and kept interstitial volume and TGF-β mRNA expression to near control levels. Furthermore, these investigators implicated the well-known interactions between angiotensin II and activation of NOS isoforms and cyclooxygenase 2 (COX-2) in the inflammatory process. Whereas UUO increased iNOS in the obstructed renal medulla and increased neuronal NOS (nNOS) and endothelial NOS (eNOS) in the cortex, losartan treatment downregulated iNOS and nNOS with unchanged levels of eNOS. In addition, obstruction increased COX-2 expression in the obstructed renal cortex. It, too, was decreased by losartan treatment. These studies suggest an important role of angiotensin-mediated profibrotic and apoptotic events occurring with renal obstruction that can be reduced with currently available inhibitors of angiotensin synthesis or receptor blockade.
The known association of aldosterone and cardiac fibrosis prompted investigators to assess whether the administration of an aldosterone antagonist could attenuate the renal fibrosis generated with obstruction. Trachtman and coworkers (2004) examined this in a rat model of UUO. Whereas 1 week of obstruction produced minimal parenchymal damage, 2 weeks of obstruction produced renal fibrosis, which was significantly reduced by administration of the aldosterone antagonist spironolactone, without raising serum potassium or aldosterone concentrations.
Nitric oxide synthases are known to be double-edged swords in the processes of tissue perfusion and tissue inflammation. Obstruction increases inducible, neuronal, and endothelial NOS and high concentrations of NO can result in peroxynitrite production. Administration of L-arginine by infusion, or even by oral administration, prevents the upregulation of iNOS, blunts the increase in renal interstitial volume, and attenuates the infiltration of the renal parenchyma by macrophages in rats with obstructed kidneys (Ito et al, 2004c; Klahr and Morrissey, 2004). Gene therapy may be another approach. Ito and colleagues (2004b) showed that the gene for iNOS could be packaged in liposomes and delivered by intraureteral administration. Transfection and NO synthesis resulted in reduced fibrosis from ureteral obstruction.
Klahr and Morrissey (2003) showed that bone morphogenic protein (BMP) 7, a structural relative of TGF-β, was effective in preventing the tubulointerstitial changes and accelerating the return of renal function in a rat model of obstruction. They demonstrated that this agent inhibited apoptosis. This group also reported that the administration of hepatocyte growth factor has similar beneficial effects and proposed that it works by suppressing expression of TGF-β and PDGF. On the other hand, BMPs have been shown to also induce the epithelial-to-mesenchymal cell transition (Hu et al, 2009), which leads to fibrosis; so, the applicability of BMPs as drug candidates is not yet settled. Pirfenidone, a drug that purportedly inhibits collagen synthesis, downregulates production of multiple cytokines, and blocks fibroblast proliferation, may be another candidate to attenuate obstruction-induced renal injury and facilitate renal remodeling (Lasky, 2004).
The pathways of apoptosis, inflammation, and fibrosis all depend upon NFκB as a common mediator. Tamada and colleagues (2006) showed that kremezin, an oral adsorbant of indoxyl sulfate, lowers activation of NFκB and reduces inflammation and fibrosis. Curcumin, an ingredient of the spice turmeric, also appears to inhibit NFκB activity and interstitial inflammation and fibrosis (Kuwabara et al, 2006). This pathway appears important in drug-induced nephrotoxicity, as well as in obstructive nephropathy.
Heme oxygenase-1 (HO-1) exerts cytoprotection from a variety of kidney injuries. One of its endogenous products is carbon monoxide (CO). Wang and colleagues (2008c) found that low-dose CO protected against the fibrosis of UUO, probably by inhibiting TGF-β1 and other mediators of fibrosis. Similarly, Iwai and colleagues (2008) showed that induction of HO-1 with prophylactic cobalt protoporphyrin protected against renal fibrosis from UUO. Thus increasing HO-1 or its products may be a fruitful approach to treating obstructive nephropathy.
Although the results of the preliminary studies are encouraging, these agents should not be prescribed to patients for this purpose at this time. Their safety and efficacy first need to be established through carefully designed and controlled clinical studies.
Compensatory Renal Growth
Compensatory renal growth (CRG) of the unobstructed kidney was first described by Hinman (1943). This phenomenon has been subsequently demonstrated in a number of other animal models of UUO (Taki et al, 1983; Peters et al, 1993). There is evidence that it occurs in the human fetus. An increase in contralateral renal volume has been detected ultrasonographically when contralateral hydronephrosis or unilateral renal agenesis is present (Mandell et al, 1993).
The mechanisms and nature of this growth are influenced by several factors including age, and degree and duration of obstruction. Both hyperplastic and hypertrophic CRG have been demonstrated (Dicker and Shirley, 1973; Castle and McDougal, 1984; Peters et al, 1993). CRG was demonstrated to decrease progressively with increasing age at which the obstruction occurred in animal models (Taki et al, 1983). Studies of humans subjected to nephrectomy, a functional surrogate for obstruction, have demonstrated that a reduction in CRG occurs with increasing age (Edgren et al, 1976). Animal experiments have also demonstrated that compensatory growth is directly proportional to the duration of obstruction (Chevalier et al, 1999). Compensatory growth is less prominent with partial than with total UUO (Chevalier and Kaiser, 1984; Eskild-Jensen et al, 2001). While the kidney enlarges, an increase in the number of nephrons or glomeruli does not occur (Peters et al, 1993). However, an increase in the length of the proximal tubule has been described, which may be due to an increase in cell size (Moller, 1988). In addition, there is augmented extracellular matrix synthesis and growth of mesangial cells (Kasinath et al, 2006; Sinuani et al, 2006). Insulin-like growth factor I (IGF-I), a mitogenic and anabolic peptide, may play a role in compensatory renal growth after obstruction. There is both animal and clinical evidence for its role. In rats, mean renal IGF-I is significantly elevated in the normal kidney compared with the contralateral 7-day obstructed kidney (Serel et al, 2000). Inferences can also be made from nephrectomy performed in animals and humans. Renal IGF-I mRNA levels are increased in immature rats previously subjected to nephrectomy (Mulroney et al, 1991). Significant increases in serum IGF-I have been demonstrated in humans after donor nephrectomy and peak 6 months after the procedure. Serum IGF-I was positively correlated with increases in renal volume demonstrated on serial postoperative imaging (Nam and Chang, 1999). It has also been demonstrated that the expression of IGF-I may be age dependent. Although renal IGF-I mRNA levels were found to be elevated after nephrectomy in immature rats, this did not occur in adult rats (Mulroney et al, 1991). Exogenous IGF-1 can attenuate renal injury from obstruction (Chevalier et al, 2000). Other growth factors, cytokines, and enzymes may be involved in regulating CRG, including IGF binding protein–3 (IGFBP-3), vascular endothelial growth factor (VEGF), matrix metalloproteinase–9 (MMP-9), interleukin-10 (IL-10), and TGF-β (Yildiz et al, 2008). Experimental studies suggest that CRG may be influenced by mitochondrial respiration (Tucci et al, 2008). The presence of compensatory growth in infants has been considered by some as an indicator that contralateral hydronephrosis is functionally significant (Koff and Peller, 1995). However, this approach has been challenged by others (Brandel et al, 1996). In addition, it was demonstrated that functional deterioration occurred in a rat model of partial UUO before compensatory growth developed in the contralateral renal unit. This implies that there may be a risk for functional renal loss if one uses only compensatory growth as an indication of correction of obstruction (Wen et al, 1999). Studies in children with unilateral renal tumors have shown that partial nephrectomy is associated with a greater degree of CRG versus nephrectomy, as assessed by ultrasonography (US) (Cozzi et al, 2007). The cause for this differential response is unknown but may be due the generation of more CRG factors in this setting.
Renal Recovery after Obstruction
The duration of obstruction has a significant influence on renal functional recovery. When acute, complete ureteral obstruction is promptly relieved, full recovery of global GFR can occur. In the rat model, after 3 days of UUO, GFR, and RBF were reduced to less than 10% of their baseline values. Both returned to their baseline within 14 days of relief of obstruction (Ito et al, 2004a). Bander and colleagues (1985) also noted complete return of GFR by 14 days after 24 hours of acute UUO, although they noted that the recovery was heterogeneous at the nephron level. Studying SNGFR, they found that approximately 15% of superficial and juxtamedullary nephrons were permanently lost, but hyperfiltration of the remaining nephrons allowed maintenance of whole kidney GFR. Longer periods of complete ureteral obstruction are associated with diminished return of GFR. Kerr (1954) reported that in dogs with complete UUO for 7 days, GFR 1 hour after relief of obstruction was 25% of the preligation GFR. GFR was then followed to assess the degree and time course of renal recovery. Maximal recovery was 58% of baseline, and this occurred within 57 days. Similar studies were conducted by Vaughan and Gillenwater (1971), who demonstrated that there was full functional renal recovery at 2 weeks after a 7-day period of UUO in dogs. This result declined to 70% recovery of GFR after 14 days of UUO, 30% after 4 weeks of UUO, and no recovery after 6 weeks of UUO.
The fate of the human kidney after prolonged periods of obstruction is less well defined and may be unpredictable. Functional recovery has been reported after a 150-day period of UUO (Shapiro and Bennett, 1976). Permanent reductions in GFR may occur after UUO or BUO in humans. However, there may be a differential pattern of recovery after BUO in adults. Jones and associates (1988) described two phases of functional improvement: an initial phase during the first 2 weeks after relief of obstruction, when tubular function improved, and a later phase occurring over the next 10 weeks, when GFR gradually improved. Patients with BUO or obstruction of a solitary kidney may also be at risk for unique sequelae such as chronic urinary acidification and concentrating defects (Berlyne, 1961).
Histopathological findings may predict recovery of renal function. The presence of increased collagen and elastin in renal parenchyma at the time of pyeloplasty has been shown to have a negative impact on recovery of renal function (Kim et al, 2005; Kiratli et al, 2008).
Renal parenchymal thickness based on computed tomography (CT) measurements has been used to estimate the renal function of chronically obstructed kidneys. One group compared renal surface areas in both kidneys calculated by multiplying the thickness (average of upper and lower pole values) by the renal length. They divided the surface area of one kidney by the sum of the surface areas of both and reported a strong correlation with differential renal function measured by nuclear medicine techniques (Feder et al, 2008). Another group measured the renal thickness at three discrete levels in the kidney and averaged these values. They reported that if the ratio of this measurement in the obstructed versus the unobstructed renal unit was less than 0.68, this correlated with a differential renal function of less than 20% (Kaplon et al, 2009). Further studies are needed to corroborate these results before this approach is used in clinical practice. Other factors influence functional return. Factors that have a positive influence on functional recovery include a smaller degree of obstruction, greater compliance of the collecting system, and presence of pyelolymphatic backflow (Shokeir et al, 2002). Conversely, older age and decreased renal cortical thickness are predictors of diminished recovery of renal function (Lutaif et al, 2003).
Nuclear renography may help predict functional recovery. An assessment of functioning cortex with such imaging is the best predictor. For example, dimercaptosuccinic acid (DMSA), a cortical agent, has been shown to be superior to tubular selective agents, such as diethylenetriaminepentaacetic acid (DTPA) or mercaptoacetyltriglycine (MAG3), for the prediction of renal recovery. This was demonstrated in a prospective study in children undergoing pyeloplasty or ureteral reimplantation for ureterovesical junction obstruction (Thompson and Gough, 2001). It was postulated that DMSA better defines the functional cortex and is less affected by the dilated collecting system and dilution by undrained urine. Similarly, when the tubular agent ortho-iodohippurate was used, whole kidney activity was less predictive than the cortical phase (Kalika et al, 1981).
Renal recovery after relief of obstruction is affected by the duration of obstruction, degree of obstruction, patient’s age, and baseline renal function. Cortical phase nuclear renograms may offer accurate prediction of the capacity of the kidney to recover after reversal of the obstruction.
Pathologic Changes of Obstruction
Distinct gross and microscopic pathologic changes may occur with obstruction of the upper urinary tract. These may be affected by the presence of infection, duration of obstruction, and intra- versus extrarenal localization of the renal pelvis.
Gross Pathologic Findings
The gross pathologic changes occurring in the kidney have been characterized in animal models and parallel those in humans. Hodson (1969) and colleagues performed unilateral ureteral ligation in a porcine model and described pathologic changes in both kidneys over several time points. Dilation of the pelvis and ureter and blunting of the papillary tips were present in the obstructed kidney at 42 hours after obstruction, and the weight of this renal unit was heavier. Pelviureteric dilation and weight further increased and the parenchyma became edematous in the obstructed kidney at 7 days. The cortex remained slightly enlarged, and there was increased calyceal dilatation at 12 days in this renal unit; at 21 and 28 days, the external renal dimensions of both kidneys were similar. However, the cortex and medullary tissue in the obstructed kidney were diffusely thinned. Ladefoged and Djurhuus (1976) evaluated partial and complete obstruction in a porcine model. They found that totally obstructed kidneys were enlarged, had a cystic appearance, and weighed less than the contralateral renal unit 6 weeks after obstruction. However, such gross differences in appearance were not present at this interval in the partially obstructed kidneys.
Microscopic Pathologic Findings
Light microscopic changes reported in the aforementioned porcine model at 42 hours after obstruction included lymphatic dilation, interstitial edema, and tubular and glomerular preservation. Collecting duct and tubular dilatation was prominent by 7 days. In addition, further interstitial edema, widening of Bowman space, tubular basement membrane thickening, cell flattening, and cytoplasmic hyalinization were demonstrated. Papillary tip necrosis, regional tubular destruction, and inflammatory cell response were noted at 12 days (Hodson et al, 1969). Interstitial fibrosis and thickening of the tubular basement membranes were reported at 16 days after obstruction in a mouse model (Sharma et al, 1993). The inner cortex demonstrated severe tubular loss, proliferation of fibroblasts, and collagen deposition 3 weeks after obstruction in the porcine kidney. Cortical thinning and development of glomerular crescents were present at the 3- to 4-week interval in this model (Hodson et al, 1969). Widespread glomerular collapse and tubular atrophy, interstitial fibrosis, and proliferation of connective tissue in the collecting system were reported at 5 to 6 weeks after obstruction in the porcine model (Ladefoged and Djurhuus, 1976). Similar findings are noted in the chronically obstructed human kidney (Figs. 40-4 to 40-6).

Figure 40–4 Sections of deep cortex and outer medulla from a patient with chronic obstructive uropathy. Tubules demonstrate thyroidization-type atrophy interspersed with mononuclear inflammatory infiltrate. Hematoxylin and eosin stain; original magnification, ×25.
(Courtesy of Dr. Sami Iskandar.)

Figure 40–5 Sections of deep cortex and outer medulla from a patient with chronic obstructive uropathy. Obsolescent glomerulus (left edge) and pool of extravasated Tamm-Horsfall protein (center) are seen. Hematoxylin and eosin stain; original magnification, ×25.
(Courtesy of Dr. Sami Iskandar.)
Figure 40–6 Sections of deep cortex and outer medulla from a patient with chronic obstructive uropathy. Glomerulus with segmental tuft sclerosis (center) and hyalinosis is seen. Hematoxylin and eosin stain; original magnification, ×100.
(Courtesy of Dr. Sami Iskandar.)
This is believed to be a result of interplay of several cellular and molecular mechanisms that collectively lead to the subtle development of tubular atrophy, macrophage infiltration/proliferation in the renal interstitial tissue, interstitial fibrosis and progressive loss of nephrons (Chevalier, 2006; Moon et al, 2006). These processes are also reviewed earlier in this chapter.
Electron Microscopic Pathologic Findings
Electron microscopic (EM) studies have confirmed the aforementioned light microscopic findings, including the presence of tubular atrophy, glomerular collapse, and renal pelvic smooth muscle atrophy at 5 to 6 weeks after obstruction (Fig. 40–7). Electron microscopic studies have also demonstrated other changes including the development of a cell-poor stroma composed of elastic and collagen fibers in the renal interstitium and obstructed portions of the collecting system (Ladefoged and Djurhuus, 1976). Collagen and elastin are normal components of the collecting system but are more prominent and have structural changes with obstruction (Gosling and Dixon, 1978; Murakumo et al, 1997).

Figure 40–7 A, Scanning electron microscopic appearance of a normal glomerular cast (×390). B, Appearance of a glomerular microvascular cast after obstruction shows capillary collapse and irregularity (×390).
(A and B, From Leahy AL, Ryan PC, McEntee GM, et al. Renal injury and recovery in partial ureteric obstruction. J Urol 1989;142:199–203.)
General Issues in Management of Patients
Diagnostic Imaging
As the clinical signs and symptoms of obstructive uropathy are so widely variable, prompt and accurate diagnosis is dependent upon appropriate imaging. The practicing urologist should be well versed in the diagnostic imaging modalities currently available, as well as their relative advantages, limitations, and appropriate modifications. An overview of current imaging techniques, with an emphasis on recent modifications, is presented here. Diagnostic tests used in the evaluation of upper urinary tract obstruction include ultrasonography, excretory urography (EXU), retrograde pyelography, antegrade pyelography, isotopic renography, computed tomography (helical), magnetic resonance imaging, and pressure flow study (Whitaker test).
Ultrasonography
Renal ultrasonography is a mainstay in the evaluation of suspected urinary tract obstruction. Although it is primarily an anatomic study, Doppler modifications may add a functional component. There is no associated ionizing radiation, and it is thus considered safe in pediatric and pregnant patients. Because there is no need for iodinated contrast material, ultrasonography can be used in those with azotemia or contrast allergy. Because it remains relatively inexpensive and widely available, ultrasonography is often a first-line investigational imaging modality to demonstrate dilatation, and it is also considered the best initial imaging modality for evaluating and following hydronephrosis (Watkin et al, 2007).
Renal parenchymal thickness can be measured readily, and cortical thinning may be indicative of chronic obstruction. The renal pelvis and calyces can be imaged, and dilatation is readily identifiable. Caution in interpretation must be exercised, however, in that hydronephrosis is an anatomic as opposed to a functional diagnosis. Specifically, caliectasis and pelviectasis both may exist in an unobstructed system. Functional inferences cannot be presumed from static images. For instance, the hydronephrosis of vesicoureteral reflux is not typically obstructive. In addition, renal sinus cysts can be misinterpreted as hydronephrosis. Conversely, early in acute obstruction, hydronephrosis may not be prominent, and the presence of an intrarenal collecting system or dehydration may lead to false-negative interpretations. A prospective study of ultrasonography in obstruction by Laing and colleagues (1985) revealed a 35% false-negative rate in acute obstruction, underscoring the need to correlate the clinical picture carefully with the radiologic findings.
Doppler ultrasonography allows measurement of the renal resistive index (RI), which has been used to assess for obstruction. The RI is defined as peak systolic velocity (PSV) minus the end-diastolic velocity (EDV) divided by the PSV. Several groups have assessed its ability to diagnose obstruction, but its utility has yet to be fully established. Platt and coworkers (1991) have suggested 0.7 as the upper limit of normal, with values greater than 0.7 reflecting elevated resistance to blood flow and thus suggesting obstructive uropathy. They subsequently reported their experience using this modality in 23 patients with acute unilateral obstruction. Three patients had false-negative studies, two of whom had pyelosinus extravasation and one of whom had been obstructed for less than 5 hours. They concluded that Doppler determination of RI was a valuable adjunct to routine sonographic evaluation of urinary tract obstruction (Platt et al, 1993). Conversely, others have found the sensitivity inadequate for the detection of obstruction. Tublin and associates (1994) reported that of 32 patients with colic, 12 of 19 patients with obstruction had normal RI, and 5 of 13 without obstruction had abnormal RIs.
One factor that may account for the dichotomy between such studies is the degree of obstruction. Chen and colleagues (1993) evaluated 27 patients with suspected obstruction by both Doppler ultrasonography and EXU. Overall, using an RI of 0.7 as the critical value, the sensitivity was only 52%. However, when correlated with degree of obstruction on EXU, RI was shown to differentiate the kidneys with mild obstruction from those with severe obstruction. In those with mild obstruction, the mean RI was only 0.64, whereas in those with severe obstruction the mean RI was 0.74, and the sensitivity of an RI greater than 0.70 for significant obstruction was 93.3%. Fung and coauthors (1994) also assessed this modality for evaluating obstruction. They measured RI in nine patients undergoing Whitaker testing for grade 3 or 4 hydronephrosis and reported that RI directly correlated with renal pelvic pressure. They determined that when renal perfusion pressures were normal, RI was less than 0.82. Major pitfalls in many of the studies assessing this modality have been the inconsistent definition of obstruction and degree of obstruction. Although the presence of hydronephrosis associated with an abnormally elevated RI may be indicative of the severity of obstruction, it is important to recognize these limitations and use other clinical information and renal functional assessment for treatment planning.
Crossing vessels are associated with ureteropelvic junction obstruction (UPJO), and their presence may influence treatment. Ultrasonographic techniques can be used to demonstrate their presence. Mearini and colleagues (2003), in a study of 21 patients with suspected UPJO, demonstrated the utility of color Doppler ultrasound scanning (CDUS) to correctly identify aberrant crossing vessels with an accuracy of 90.4%. Endoluminal sonography (EUS) is another useful means to evaluate a UPJO for a crossing aberrant vessel (Hendrikx et al, 2006). EUS uses a catheter-based sonographic probe, inserted under endoscopic and fluoroscopic control, that delivers a 360-degree cross-sectional view for assessing the ureter and periureteral structures. Recently, three-dimensional (3D) reconstruction of the two-dimensional (2D) endoluminal sonographic image has been shown to augment the diagnostic accuracy of this modality for comprehensive elucidation and assessment of the vascular morphology of the crossing vessel (Lin et al, 2008). Contrast-enhanced color Doppler imaging (CECDI) is another relatively new promising technique that is currently under evaluation. It has been compared with CT and magnetic resonance imaging (MRI) for the detection of crossing vessels in suspected ureteropelvic junction obstruction (UPJO). The CECDI technique uses galactose-based, echo-enhancing microbubble contrast agents that are administered intravenously, either as a single injection or as a fractionated, slow, continuous infusion. This is followed by color Doppler amplitude/frequency/pulsed-wave spectral imaging, which differentiates between arterial and venous flow signals. This permits identifying the presence of a crossing artery, vein, or both. Recently, Mitterberger and colleagues compared CECDI, MRI, and CT in correctly identifying the crossing vessels detected in patients with UPJO being subjected to laparoscopic pyeloplasty. The reported accuracies for CECDI, MRI, and CT were 100%, 100%, and 93%, respectively (Mitterberger et al, 2008).
Excretory Urography
Long considered the “gold standard” for the evaluation of the upper urinary tract, EXU has been supplanted by other modalities for many of its prior indications. Nevertheless, it provides both anatomic and functional information. Acute urinary obstruction may be inferred from the functional abnormality of a delayed nephrogram and pyelogram on the affected side or sides. Delayed images may then ultimately reveal the anatomic level of obstruction and perhaps causation. In addition, other signs may be present that may indicate chronicity of obstruction such as parenchymal thinning, extreme calyceal blunting, and ureteral tortuosity.
As the imaging is dependent upon glomerular filtration and renal concentration of the contrast medium, the utility of EXU is limited in those with renal insufficiency. Furthermore, the risk of contrast nephropathy increases with increasing serum creatinine. EXU, therefore, should not be performed in subjects with renal insufficiency, those who are at higher risk for developing contrast-induced nephropathy, or those with history of contrast allergy. Radiation exposure limits its utility in pregnancy, although abbreviated protocols have been established (Zagoria and Tung, 1997).
Retrograde Pyelography
Retrograde pyelography accurately defines ureteral and collecting system anatomy, including the location of an obstructive lesion and its extent. It should be considered in those who have renal insufficiency or have other risks for receiving intravenous iodinated contrast material. It may also be used in cases in which anatomy is not sufficiently defined with other imaging studies. In essence, a loopogram is another form of retrograde pyelography and may be useful in evaluating patients with cutaneous urinary diversion when obstruction is suspected.
Antegrade Pyelography
This technique may be helpful when other imaging studies do not adequately define collecting system or ureteral anatomy and when retrograde pyelography is not technically feasible.
Whitaker Test
First described by Whitaker in 1973, this study involves measurement of renal pelvic pressure during infusion of either saline or contrast material into the collecting system through a percutaneous needle or nephrostomy at a fixed rate of 10 mL/min. A catheter is placed in the bladder to monitor intravesical pressure, which is subtracted from the measured collecting system pressures to calculate the “true pressure” within the pelvis. A true intrapelvic pressure of less than 15 cm H2O is considered normal, greater than 22 cm H2O indicative of obstruction, and between 15 and 22 cm H2O indeterminate. Although its reliability to detect obstruction and differentiate degree of obstruction has been established in animal models (Ryan et al, 1989), the clinical utility of this test has been advocated by some and questioned by others. For example, one group reported that it was a valid test to confirm ureteral obstruction after renal transplantation (Kashi et al, 1993). However, others have reported a sensitivity and specificity of only 79% and 50% in this setting (Sperling et al, 2000).
Other concerns regarding potential shortcomings of the Whitaker test have been noted. Mortensen and colleagues (1983) reported wide variation in pelvic pressures in a normal porcine model, questioning the definition of a “normal” study. It has also been noted that a small, noncompliant obstructed system may give rise to a more rapid increase in pressure than a large, dilated obstructed system (Wahlin et al, 2001). Modifications have been suggested to overcome this pitfall. Individualized infusion rates based on maximum physiologic urine output have been advocated by some (Fung et al, 1995). Wahlin and colleagues (2001) proposed measuring flow as a function of pressure over a range of physiologic pressures. Resistance was then calculated and used to categorize responses as nonobstructed, indeterminate, or obstructed. They found that the major benefit of this modification was that it allowed identification of obstruction in some patients categorized as indeterminate with the standard Whitaker test. These noted discordant results and the invasiveness of the study reflect the Whitaker test’s limited applicability in contemporary clinical practice.
Nuclear Renography
Nuclear renography is a useful, noninvasive test for evaluating patients with suspected obstruction. It provides a functional assessment without exposure to iodinated contrast material. Radiopharmaceuticals for renography are selected on the basis of the function to be studied. The glomerular agent technetium (Tc) 99m DTPA and the tubular agent 99mTc-MAG3 are most commonly used in the evaluation of obstruction. 99mTc-MAG3 has a high renal extraction rate, associated with rapid clearance, lower radiation dose, and tubular secretion. 99mTc-MAG3 has a 55% renal uptake in contrast with a 20% renal uptake associated with 99mTc-DTPA (Tremel et al, 1996). All radiopharmaceutical tracers are administered intravenously, and their uptake and subsequent clearance can then be evaluated and quantitated scintigraphically. From these data, relative renal function can be calculated. Obstruction can be assessed by measuring the clearance curves, either from a visual assessment of the pattern or from calculation of the half-time (time at which 50% of the radiopharmaceutical is eliminated from the collecting system). By convention, a half-time less than 10 minutes is considered normal, greater than 20 minutes is considered obstructed, and between 10 and 20 minutes is equivocal. Tracer clearance can be spuriously delayed because of renal insufficiency and the presence of vesicoureteral reflux, and some have suggested that renal immaturity in neonates may generate false-positive studies (Karam et al, 2003).
In order to detect obstruction, a high-flow state may be necessary. Therefore patients should be well hydrated to prevent misinterpretation related to low-flow states. Theoretically, bladder catheterization should be performed to maintain low intravesical pressure. However, in clinical practice this is used only in certain cases, such as suspected lower urinary tract obstruction, vesicoureteral reflux, neurogenic or noncompliant bladder, or low-lying, pelvic kidneys from which the renal signal may be obscured by intravesical radiopharmaceutical (Karam et al, 2003). The diuretic renogram is a modification designed to maximize flow and potentially distinguish truly obstructed collecting systems from those that are dilated but unobstructed. Because a given patient’s response to the diuretic may be affected by the patient’s baseline renal function, adjustments may need to be made on the basis of creatinine clearance (Upsdell et al, 1988).
In diuretic renography, as classically described, the diuretic, typically furosemide (F), is administered 20 minutes after the tracer to induce a brisk diuresis (F+20 study). Others have suggested alteration of diuretic timing to coincide with tracer administration (F+0) or precede it by 15 minutes (F−15). English and colleagues (1987) recognized that some patients with a partial obstruction may eliminate the tracer in the 20 minutes before the induction of diuresis using the standard F+20 sequence. To address this, they advocated administration of diuretic 15 minutes before injection of the radiopharmaceutical (F−15) so that initial tracer clearance could be studied during the period of maximal diuresis. Thirty-five renal units with hydronephrosis having equivocal or normal standard (F+20) diuretic renograms were evaluated by English and colleagues using the F−15 sequence. Using contralateral normal kidneys for comparison, they selected a clearance half-time of less than 5 minutes as normal, greater than 10 minutes as obstructed, and between 5 and 10 minutes as equivocal. With these criteria, 13 of the kidneys were demonstrated to be obstructed, and 18 were shown to be unobstructed. Only four kidneys remained in the equivocal range, underscoring the utility of this modified approach. This has also been confirmed in a crossover designed study demonstrating that although an F+20 study is reliable when obstruction is demonstrated, both the F−15 and F+0 sequences can induce obstructed patterns in previously equivocal cases (Turkolmez et al, 2004). A study by Tripathi and colleagues (2004), who evaluated the outcome of (F+0 renography) while investigating children with hydronephrosis, demonstrated that the sensitivity, specificity, and accuracy were 100%, 78%, and 83%, respectively. Liu and colleagues (2005) showed that the F+0 protocol had the advantage of a shorter time lag between the administration of furosemide and conclusion of the study, with earlier bladder filling than the F−15 protocol. With the emergence of such techniques in isotopic renography, the differential renal function and drainage can be estimated with greater precision (Frøkiaer et al, 2007).
Computed Tomography and Magnetic Resonance Imaging
Cross-sectional imaging, provided by CT and magnetic resonance urography (MRU), generates greater anatomic definition of abdominal and retroperitoneal anatomy than EXU or ultrasonography. Both CT and MRU provide superior imaging of the obstructed upper urinary tract as compared to EXU (Kemper et al, 2006). Unenhanced CT is the most sensitive method of detecting urinary tract stones and is currently the preferred imaging modality for evaluating most patients with suspected renal colic. Other advantages include its speed, reproducibility, and ability to detect other pathologic entities (Ulahannan et al, 2008). EXU currently has limited role, because noncontrast CT has been shown to consistently outperform it for detecting renal/ureteral stones (Shine et al, 2008; Stacul et al, 2008).
Noncontrast CT directly demonstrates calculi classically considered radiolucent when evaluated by plain radiography, including uric acid, xanthine, dihydroxyadenine, and many drug-induced stones. Exceptions, however, are calculi composed of protease inhibitors, which are not visualized by noncontrast CT (Gentle et al, 1997). Secondary CT signs of obstruction such as ureteral dilatation, nephromegaly, decreased parenchymal density of the involved kidney as compared with the contralateral renal unit, perinephric stranding, or fluid can facilitate the diagnosis of acute obstruction. These signs have been reported to have a positive predictive value of 99% and negative predictive value of 95% for identification of acute ureteral obstruction (Smith et al, 1996). This is also an excellent technique for evaluating patients suspected of having chronic obstruction who have renal insufficiency or other contrast risks.
Contrast-enhanced CT has also been advocated for the evaluation of patients with chronic obstructive uropathy and normal serum creatinine. In addition to the aforementioned anatomic details afforded by noncontrast CT, functional evaluation including calculation of differential GFR is possible. Abou El-Ghar and colleagues (2004) compared contrast-enhanced CT with EXU and nuclear renography in 65 patients. CT had significantly improved sensitivity for identification of the cause of obstruction compared with EXU. Furthermore, they reported an excellent correlation between isotope and CT-estimated GFR. Multiphasic helical CT has also been shown to be useful in surgical planning for ureteropelvic junction obstruction, with sensitivity for detection of crossing vessel of 97%, specificity of 92%, and with an overall accuracy of 96% (El-Nahas et al, 2004).
A number of advances in MRI technology have facilitated the evaluation of patients with obstruction of the urinary tract. There are a number of different techniques used to generate MRI images. Comprehensive MRI includes static imaging (MRU), dynamic imaging (dy-MRI), and MR angiography (MRA). Magnetic resonance urography (MRU) can be executed essentially with two different imaging techniques: (1) static-fluid MRU that relies heavily on the T2-weighted turbo spin echo (TSE) sequences, and (2) gadolinium-enhanced excretory MRU, a dynamic sequence that relies on the administration of gadolinium with or without a diuretic. The image quality of an excretory gadolinium-enhanced MRU can be considerably improved by using intravenous hydration and diuretics (Ergen et al, 2007). Recent advances and emergence of newer techniques of MRU, such as fast spin echo (FSE) and postprocessing maximum-intensity projection (MIP), have advantages over the previously employed single-shot MRU approach. The accuracy of the former for identifying noncalculous obstruction was reported to be 93% as compared with 89% for the latter (Abou El-Ghar et al, 2008a). T2-weighted MRU is an excellent imaging modality for demonstrating an obstructed renal unit (Nolte-Ernsting et al, 2003). In this approach, gadolinium contrast (Gd-MRI), intravenous fluids, and furosemide are administered. MRU has been compared to EXU, and the former has been found to be superior in most cases. A prospective study compared it with EXU in patients with ureteral obstruction (Karabacakoglu et al, 2004). The accuracy of diuretic MRU for detection of obstruction was demonstrated to be 93% in those with obstructing stones and 100% in those with obstruction related to strictures or congenital anomalies, whereas the accuracy of EXU was 96% and 55%, respectively. A study by Khanna and colleagues (2005), comparing the diagnostic utility and accuracy of MRU versus EXU in 48 patients with obstructive uropathy, concluded that MRU was superior to EXU in patients with moderate to severe dilatation, staghorn and ureteral calculi, impaired renal function, extrinsic ureteric, and UPJ obstruction. However, they also found that EXU was better in depicting small calculi and mild hydronephrosis (Khanna et al, 2005) (Figs. 40-8 and 40-9).
MRU may be used to assess renal function. It has been demonstrated to have an excellent correlation with the renal isotope GFR in the adult (Abo El-Ghar et al, 2008b) and pediatric patients (Jones et al, 2008) with obstructed kidneys. The incorporation of intravenous administration of gadopentetate-DTPA has allowed a dynamic, functional assessment of the collecting system that correlates well with diuretic renal scintigraphy, yet provides far greater anatomic detail than nuclear studies. Differential GFR can be assessed with postimaging processing, and contrast washout can be measured to calculate renal clearance, differentiating dilated systems from obstructed systems (Rohrschneider et al, 2002; Chu et al, 2004). MRU with the contrast agent gadopenteate dimeglumine can be used to estimate renal function because it is filtered by glomeruli and is neither secreted nor reabsorbed by the renal tubules. Studies indicate the possibility of estimating single-kidney function with this technique (Hackstein et al, 2004; Krishnamurthi et al, 2005; O’Dell-Anderson et al, 2006).
Comprehensive MRI, including the incorporation of magnetic resonance angiography (MRA), is a useful modality for the evaluation of patients with UPJO. The sensitivity, specificity, and accuracy of this approach for identification of crossing vessels has been reported to be 95%, 94%, and 94%, respectively (El-Nahas et al, 2007). Cost, availability, time for acquisition of images, and need for sedation in pediatric patients have all been cited as possible limitations of this technique, but the superior anatomic detail, functional assessment, elimination of risk of contrast-induced nephropathy, and lack of ionizing radiation make this an attractive option. The risk of nephrogenic systemic fibrosis associated with the use of some gadolinium agents (especially gadodiamide) in patients with renal insufficiency (GFR < 30 mL/min), limits the utility of using contrast MRI in such patients (Broome et al, 2007; Frøkiaer and Zeidel, 2007; Sadowski et al, 2007; Abou El-Ghar et al, 2008b). The absence of ionizing radiation has allowed its use in the assessment of children, women of child-bearing age, and pregnant patients (Jorgensen et al, 2006) with flank pain and hydronephrosis, which is further explored in the discussion of hydronephrosis of pregnancy later in this chapter. In children MRU has the potential to replace conventional uroradiological diagnostic tests in the near future. The present level of evidence does not suggest that MRI is clearly superior to combined ultrasonography (US) and CT imaging for the routine diagnosis and evaluation of obstructive uropathy.
On the whole, both MRU and CT have critical roles in evaluating select patients with urinary tract obstruction. Although these studies can estimate renal function (He and Fischman, 2008), nuclear renography remains the current gold standard.
Hypertension
Hypertension can be precipitated by ureteral obstruction and is a well-recognized sequela of BUO or obstruction of a solitary kidney. Vaughan and Gillenwater (1973) noted hypertension in 17 of 22 patients with BUO, which resolved in 15 subjects upon relief of BUO. This response has also been demonstrated in pregnant patients with BUO (Satin et al, 1993). Patients with BUO are typically volume overloaded. Gulmi and colleagues (1989) measured ANP and plasma renin activity (PRA) in nine patients with BUO before and after relief of obstruction and compared them with those of age-matched control subjects. ANP was significantly increased in the BUO group prior to relief, and progressively returned to normal after drainage. Conversely, PRA was depressed prior to relief of BUO. These findings are suggestive of a volume-mediated mechanism for hypertension in BUO. Hypertension is significantly less common, however, with UUO (Vaughan and Sosa, 1995). In contrast to the BUO model, in UUO the contralateral, unobstructed kidney compensates and eliminates excess volume and solutes. Renin activation and resultant angiotensin II generation have been demonstrated in animal models of UUO and may be the mechanism by which new-onset hypertension occurs in this setting. Pain may be another contributing factor (el-Dahr et al, 1993). In summary, there is a good chance of reversal of new-onset hypertension with relief of BUO, but this is less likely with UUO.
Renal Drainage
Ureteral obstruction that is symptomatic, accompanied by fever, complicated by an undrained infection, or determined to be high grade, bilateral, or inducing renal failure warrants immediate drainage of the affected renal unit(s).
Minimally invasive endourologic and interventional radiologic techniques allow prompt drainage of the obstructed kidney. These measures may allow temporary drainage until a definitive procedure is performed or, in some circumstances, may be a permanent form of management. Urine specimens for urinalysis and culture should be obtained from the obstructed renal unit at the time of relief of obstruction when infection is suspected. Antibiotic therapy is started if these tests are indicative of infection or there are clinical signs and symptoms of infection.
The relative merits of indwelling ureteral stents and percutaneous nephrostomy tubes have been evaluated by several groups. Indwelling stents obviate the need for external collection devices but are associated with bothersome voiding symptoms. In spite of this, prospective studies have demonstrated that there is no statistically significant difference in health-related quality of life (Joshi et al, 2001; Mokhmalji et al, 2001). The choice of drainage ultimately depends on the clinical setting. If the patient has an uncorrectable coagulopathy or platelet abnormality, ureteral stenting is indicated. There does not appear to be a significant advantage of either approach in those requiring drainage for stone-related problems (Pearle et al, 1998; Mokhmalji et al, 2001). Compared with percutaneous nephrostomy placement, stent insertion may require greater x-ray exposure (Mokhmalji et al, 2001). This may be of concern in pregnant patients, particularly early in gestation when the fetus is most sensitive to radiation effects (McAleer and Loughlin, 2004). Ultrasound-guided ureteral stent placement is an option in this setting (Jarrard et al, 1993). Nephrostomy tube drainage is also an option for pregnant patients, and radiation exposure can be limited with the use of ultrasound guidance (Denstedt and Razvi, 1992; Agostini et al 2003). Percutaneous nephrostomy should be strongly considered if pyonephrosis is suspected. However, if it is not suspected and thick, purulent fluid is obtained from the kidney at ureteral stenting, placement of a large-diameter stent is recommended. If this does not provide satisfactory drainage, percutaneous nephrostomy should be performed. Percutaneous nephrostomy also allows estimation of differential renal function that can be used in making decisions regarding renal salvage (Al-Hunayan et al, 2008). Percutaneous nephrostomy is also a bailout procedure when retrograde stenting fails or is not feasible.
Ureteral stenting may not be as effective for treating patients with extrinsic ureteral obstruction. Docimo and Dewolf (1989) reported a mean 43% failure rate in ureteral stents placed for extrinsic ureteral obstruction, the majority related to malignancy. This was subsequently confirmed in a prospective study evaluating success rates for retrograde ureteral stenting (Yossepowitch et al, 2001). Initial retrograde access failed in 27% of patients with extrinsic ureteral obstruction, compared with only 6% of those with intrinsic obstruction. At 3-month follow-up, 56.4% of stents placed for ureteral obstruction had failed. Of note, on multivariate analysis, stent diameter did not predict risk of stent failure. Chung and colleagues (2004) similarly identified an overall 42% rate of stent failure in patients with extrinsic obstruction of the ureter and additionally noted that 43% of those failures occurred within 6 days of the initial placement. A diagnosis of cancer, metastatic disease requiring chemotherapy or radiation, and renal insufficiency were predictors of stent failure in this series. Some have advocated the placement of two parallel ureteral stents to provide better drainage as an alternative to percutaneous nephrostomy (Liu and Hrebinko, 1998). Closer monitoring for stent failure should thus be considered in patients with extrinsic ureteral obstruction (Ku et al, 2004). Rosevear and colleagues (2007) reviewed their 9-year experience of managing extrinsic ureteral obstruction with retrograde stenting and found an overall success rate of 84%. They also found that a higher serum creatinine value was the only factor that was significantly associated with stent failure (Rosevear et al, 2007). The association of stent failure and poor renal function has also been reported by others (McCullough et al, 2008). The presence of extrinsic ureteral obstruction due to bladder or prostatic pathology, especially advanced malignancies, is another risk factor for stent failure (Danilovic et al, 2005). Encrustation is one of the causes of stent failure. This occurs commonly in pregnant patients, which may be due to increased calcium excretion during pregnancy (Goldfarb et al, 1989). Other reported risk factors for encrustation include urinary tract infection (UTI), stasis, dehydration, renal insufficiency, prolonged dwell time, and history of nephrolithiasis (Singh et al, 2001). A positive correlation between composition of the respective stones and stent encrustations has been reported (Rouprêt et al, 2005).
Choice of Surgical Intervention
After the acute obstruction has been addressed, definitive management is based upon the cause of the obstruction, the functional recovery of the affected kidney, and the condition of its counterpart, and the patient’s age and medical status. Endoscopic, open, or laparoscopic ablative and reconstructive procedures may all be used. Indications and pertinent preoperative, intraoperative, and postoperative considerations are discussed elsewhere in this text. The decision to remove a kidney should be made only after the affected kidney has been adequately drained for a sufficient period of time, 6 to 8 weeks based on the results of animal experimentation (Kerr, 1954). Split renal function (SRF) can be assessed by measuring creatinine or inulin clearance (both surrogates of glomerular filtration) directly from bilateral nephrostomy tubes or a nephrostomy tube, and an indwelling urethral catheter when there is complete UUO and the other renal unit is not obstructed. However, nuclear imaging techniques are more commonly used to assess renal function in this setting.
A less-than-10% contribution to global renal function has been proposed as the threshold for nephrectomy, although others have used higher values (Thompson and Gough, 2001). Another criterion has been the ability of the affected renal unit to provide sufficient function to prevent dialysis dependence if the contralateral kidney were removed. These criteria were not generated by prospective study but by clinical inference from functional reconstructive outcomes. There is conflicting evidence in children regarding this threshold. One group reported that renal units with less-than-10% renogram-derived differential function in children have been shown to derive no benefit from reconstruction (Dhillon, 1998). Another group found that in children with moderate hydronephrosis (initial SRF <10%) significant improvement of SRF occurred one year following pyeloplasty (Wagner, 2008). In adults, a GFR of less than 10 mL/min/1.73 m2 in the affected kidney successfully predicted renal function that did not stabilize or improve after surgical correction of obstruction (Khalaf et al, 2004). Another conflicting study showed that the renal function improvement following pyeloplasty in adult obstructed kidneys may not occur if the initial SRF was less than 30% (Ortapamuk et al, 2003). The decision to proceed with nephrectomy in a patient with significant global renal insufficiency, however, should not be based solely on the aforementioned criteria because this could hasten dialysis dependence and dramatically affect quality of life. The patient may prefer life with a stent or percutaneous nephrostomy, or an attempt at surgical reconstruction.
Pain Management
Five classes of drugs are used to treat pain associated with acute renal colic, namely, nonsteroidal anti-inflammatory drugs (NSAIDs), narcotic analgesics, calcium channel blockers, corticosteroids, and α1 blockers (Micali et al, 2006). NSAIDs and narcotic analgesics are now most commonly used (Davenport et al, 2005; Holdgate and Oh, 2005; Holdgate and Pollock, 2006). Cochrane meta-analysis studies have demonstrated the effectiveness of both agents but suggest that NSAIDs are preferred (Holdgate and Pollock, 2004, 2005; Das et al, 2006). Other investigators have demonstrated the superiority of NSAIDs (Lee et al, 2005; Engeler et al, 2008). The present level of evidence supports the role of NSAIDs as first-line drugs for the management of renal colic presenting to the emergency department, with narcotics being reserved as second-line drugs.
Both classes of medications may be administered parenterally, orally, or as a rectal suppository. NSAIDs are nonopioid analgesics that, unlike narcotics, target the inflammatory basis of pain. Prostaglandins, generated from arachidonic acid metabolism mediated by both iso forms of cyclooxygenase, potentiate pain receptors. Therefore inhibition of prostaglandin synthesis prevents this potentiation of nociceptors (Mense, 1983). Narcotic analgesics have a rapid onset but may promote nausea, emesis, constipation, urinary retention, hypotension, respiratory depression, excessive sedation and have a potential for addiction (Lasoye et al, 2004; Holdgate and Pollock, 2006).
Increases in collecting system pressure and ureteral wall tension are proposed mechanisms of renal colic (Holmlund, 1983). Primate models reveal that distention-mediated activation of renal pelvis mechanoreceptors results in spinothalamic (pain pathway) C fiber excitation. The mean threshold pressure to elicit this primate response was 32 mm Hg. This is similar to the 30-mm Hg proposed threshold for evoking pain in humans (Ammons, 1992). Interventions that reduce collecting system pressure should theoretically reduce pain.
NSAIDs have been demonstrated to reduce collecting system pressure. Pretreatment with indomethacin significantly blunted the rise in pelvic pressure and RBF in pigs with UUO (Frøkiaer et al, 1993). Indomethacin administered 30 minutes after UUO reduced an already elevated renal pelvic pressure by approximately 30% in rats (Sjodin et al, 1982). A study of four different NSAIDs in dogs with acute obstruction showed 25% to 58% reductions in renal pelvic pressure after administration of these drugs, which were most pronounced after the first dose (Gasparich and Mayo, 1986). A concomitant reduction in RBF induced by NSAIDs is thought to be one of the mechanisms for decreasing collecting system pressure. This has been demonstrated in a canine model of UUO in which the administration of ketorolac, an NSAID, induced prompt reduction in both RBF and intrapelvic pressure (Perlmutter et al, 1993). A second potential mechanism involves regulation of aquaporin water channels. COX-2 expression is upregulated in the obstructed ureter (Nakada et al, 2002). There is also a downregulation of AQP2 water channels associated with this COX-2 induction, and this promotes diuresis after obstruction is relieved. Rats treated with a COX-2 inhibitor during obstruction had only a 28% reduction of AQP2, attenuating the diuresis occurring after release of UUO (Cheng et al, 2004).
The choice of pain management should be based on the patient’s clinical profile. NSAIDs should not be used in patients with renal insufficiency, because this could be exacerbated by the induced reduction in RBF. COX-1 inhibitors should not be administered to patients at risk for gastrointestinal bleeding or when optimal platelet function is needed. Although COX-2 inhibitors are attractive on a pathophysiologic basis, the market withdrawal of some COX-2 inhibitors, related to increased risk of cardiac morbidity, underscores the need for prospective trials to assess their long-term safety in managing patients with renal colic.
The administration of α1 blockers, calcium channel blockers, and corticosteroids have been used for medical expulsive therapy. Studies have demonstrated the utility of the first two medications to facilitate stone passage, while the benefit of the latter one is questioned. The use of α1 blockers for this purpose has also been shown to reduce the requirement for analgesics (Micali et al, 2007; Singh et al, 2007; Sterrett et al, 2008; Wang et al, 2008a). Anticholinergic agents have been used in the setting of colic but their benefits have not been established (Holdgate and Oh, 2005; Prcić et al, 2006).
Patients may be fluid depleted as a result of anorexia and emesis, and therefore should receive intravenous hydration. However, there is no evidence that intravenous hydration facilitates stone passage (Springhart et al, 2006; Worster and Richards, 2005).
Postobstructive Diuresis
Mechanisms
Following the relief of urinary tract obstruction, postobstructive diuresis—a period of significant polyuria—may ensue. Urine outputs of 200 mL/hr or greater may be encountered. Although this occurs mainly after relief of BUO or obstruction of a solitary kidney, it can rarely occur when there is a normal, contralateral kidney (Schlossberg and Vaughan, 1984). The diuresis is typically a normal physiologic response to the volume expansion and solute accumulation occurring during obstruction. Sodium, urea, and free water are eliminated, and the diuresis subsides after solute and fluid homeostasis is achieved. With the return of homeostasis, the period of diuresis ends (Loo and Vaughan, 1985).
However, a “pathologic” postobstructive diuresis may ensue, characterized by inappropriate renal handling of water or solutes, or both. It is due to a number of mechanisms previously reviewed in this chapter, including a derangement of the medullary solute gradient and a number of altered signaling and transport pathways. Downregulation of sodium transporters with subsequent impaired sodium reabsorption in the thick ascending limb of the Henle loop prevents maintenance of the medullary interstitial solute gradient, promoting a continued diuresis (Rokaw et al, 1996). The increased endogenous production and altered regulation of ANP induce a saline diuresis (Kim et al, 2001b). In addition, other natriuretic peptides, such as the Dendroaspis natriuretic peptide, may play a role (Kim et al, 2002). Pathologic postobstructive diuresis is also marked by poor responsiveness of the collecting duct to antidiuretic hormone (ADH). This is thought to be due to a downregulation of aquaporin water channels in this segment of the nephron and perhaps in the proximal tubule, which has been demonstrated in experimental models of UUO and BUO (Nielsen and Agre, 1995; Frøkiaer et al, 1996; Kim et al, 2001a; Li et al, 2003).
Various reasons have been proposed for the rare occurrence of postobstructive diuresis with release of UUO and a normal contralateral kidney. GFR may be atypically preserved in the setting of distal tubular damage such that the kidney filters a normal volume but there is limited free water reabsorption. Alternatively, a pronounced aquaporin channel defect may be present, causing diminished free water absorption in this setting (Schlossberg and Vaughan, 1984; Li et al, 2003). An experimental study by Nørregaard and colleagues (2007) concluded that decreased Na+,K,+,2Cl− cotransporter type 2, collapse of the inner medulla osmotic gradient, and suppressed phosphorylated renal aquaporins (AQP2) may be responsible for the impaired urine-concentrating capacity in the chronic postobstructive phase following release of ureteral obstruction. The rarity of this condition has been ascribed to compensatory retention of salt and water by the contralateral renal unit (Frøkiaer et al, 2007).
Clinical Management of Postobstructive Diuresis
The majority of patients do not demonstrate a clinically significant postobstructive diuresis following relief of urinary tract obstruction. Those who are susceptible to this phenomenon typically have signs of fluid overload including edema, congestive heart failure, or hypertension (Loo and Vaughan, 1985). The most common clinical setting is release of urinary retention. A catheter should be placed to drain the bladder rapidly in those with urinary retention. There is no role for gradual bladder decompression, because this has not been demonstrated to limit hematuria or the risk of postobstructive diuresis (Nyman et al, 1997).
Subjects in whom BUO or UUO in a solitary kidney is relieved should be monitored for a postobstructive diuresis. Serum electrolytes, magnesium, blood urea nitrogen (BUN), and creatinine should be checked. The intensity of monitoring depends on presence of risk factors for postobstructive diuresis and the subject’s mental status, renal function, and electrolyte status. Those with normal renal function and electrolytes, no evidence of fluid overload, and who are mentally alert should have their vital signs and urine output monitored. They are allowed free access to oral fluids, and if they do not manifest signs of a postobstructive diuresis they can be discharged and return later for further urologic evaluation and care. If they show signs of a postobstructive diuresis but are alert, able to consume fluids, and have normal vital signs, observation is continued and the patients may consume fluids as desired. This is a physiologic diuresis that, in the majority of cases, resolves when free water and excess solutes are eliminated. Serum electrolytes, BUN, magnesium, and creatinine are checked daily until the diuresis resolves. If patients have signs of fluid overload, azotemia, or poor cognitive function, or if hypotension or other indicators of hypovolemia develop, more intense monitoring should be instituted. Vital signs and urine output are checked more frequently. Electrolytes, BUN, magnesium, and creatinine are assessed every 12 hours, and more frequently if necessary. Urinary osmolarity should be checked in this setting. Hypo-osmolar urine is indicative of a primary water diuresis as opposed to a solute diuresis. Of note, an initial solute diuresis may convert to a pathologic water diuresis, underscoring the need for obtaining a baseline urine osmolarity and continued monitoring of this parameter.
The clinically stable patient with good cognitive function should be given free access to oral fluids. Intravenous fluids should probably not be administered, because this may prolong the period of diuresis. However, there may be a theoretical role for maintenance of volume expansion in this setting. Gulmi and associates (1995) demonstrated improved GFR in dogs undergoing volume expansion just prior to relief of BUO. This is linked to increased generation of ANP and the salutary effects of this peptide on RBF and GFR. A clinical trial is needed to determine whether this would facilitate recovery of GFR in humans.
Those with poor cognitive function should receive intravenous hydration, but below the normal maintenance amounts. The majority of these groups also have a self-limiting physiologic diuresis. On rare occasions, a pathologic diuresis develops and the patients can become hypovolemic because of excess water loss. They can develop electrolyte abnormalities as a result of this excess water loss, salt and potassium losses, or both. Massive polyuria with sodium, chloride, potassium, bicarbonate, phosphate, calcium, and magnesium wasting in this setting may promote electrolyte disturbances. These patients warrant the most intense monitoring and require careful electrolyte and fluid replacement, initially by an intravenous route. The urine is usually isosthenuric initially and intravenous fluid replacement with 0.45% saline administration at a rate lower than the urine output is recommended (Frøkiaer and Zeidel, 2007). Changes in the type and amount of intravenous fluid administration are based on the patient’s clinical status, serum, and urinary electrolytes. Some patients have salt wasting associated with hyponatremia and hyperkalemia, mimicking adrenal insufficiency. This has been reported to occur mainly in children (Melzi et al, 1995). It is thought to be due to tubular resistance to aldosterone, and supporting evidence for this is the significantly increased serum aldosterone levels reported in these cases. The underlying cause may be a reduction in aldosterone receptors (Kuhnle et al, 1993).
Experimental Modulation of Postobstructive Diuresis
Animal and cell culture experiments demonstrate the potential of pharmacologically attenuating postobstructive diuresis. Ureteral obstruction induces expression of COX-2 in collecting duct cells (Guan et al, 1997). Evidence suggests that the downregulation of AQP2 receptors is mediated by COX-2. Administration of COX-2 inhibitors prevented the downregulation of AQP2 and significantly diminished postobstructive diuresis in rats with BUO (Cheng et al, 2004). In addition, with ureteral obstruction, there is blunted cAMP generation in response to vasopressin (Kim et al, 2001a). Vasopressin-induced, cAMP-mediated pathways induce phosphorylation and subsequent membrane insertion of AQP2 (Nishimoto et al, 1999; Van Balkom et al, 2002). A cAMP-independent, cyclic guanosine monophosphate (cGMP) pathway has been demonstrated in both in-vitro and in-vivo models to allow membrane insertion of AQP2 (Bouley et al, 2000). Acute exposure to the phosphodiesterase type 5 inhibitor sildenafil citrate elevated intracellular cGMP and has been shown to facilitate collecting duct accumulation of AQP2 (Bouley et al, 2005). Although such data suggest that postobstructive diuresis can be manipulated pharmacologically, it is unclear whether such manipulation would be ultimately beneficial or harmful.



